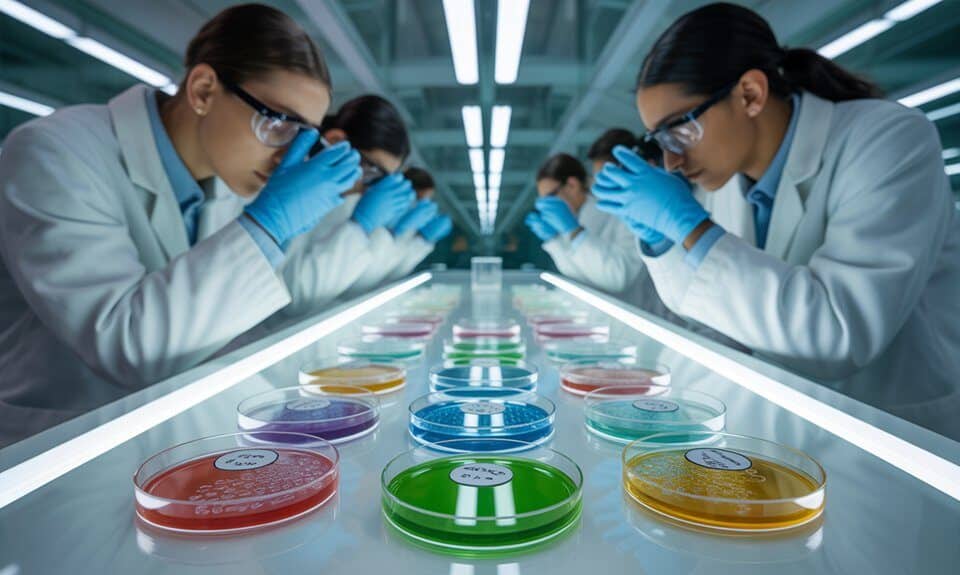
Anthropics Petri-Modell-Vergleich

ChatGPT, ein von OpenAI entwickelter Chatbot, hat seit seiner Einführung im Jahr 2020 viel Aufmerksamkeit auf sich gezogen. Das System nutzt modernste Deep-Learning-Technologie, um menschenähnliche Antworten auf eine Vielzahl von Themen zu generieren und hat bereits in verschiedenen Anwendungsbereichen wie Kundenservice, Bildung und Unterhaltung Verwendung gefunden.
Obwohl ChatGPT aufgrund seiner Fähigkeit, menschenähnliche Antworten zu generieren, als beeindruckend angesehen wird, gibt es auch Bedenken hinsichtlich des Potenzials des Systems, Missbrauch oder Manipulation zu ermöglichen. So könnten zum Beispiel bösartige Akteure Chatbots wie ChatGPT nutzen, um automatisch gefälschte Nachrichten oder Social-Media-Beiträge zu erstellen, die schwer von echten Inhalten zu unterscheiden sind.
Darüber hinaus wurde ChatGPT auch wegen seiner Fähigkeit, sexistische oder rassistische Aussagen zu machen, kritisiert. Um diese Probleme anzugehen, haben die Entwickler von OpenAI angekündigt, das System in Zukunft genauer zu überwachen und zu kontrollieren.
Trotz dieser Herausforderungen und Bedenken hat ChatGPT das Potenzial, in der Zukunft eine wichtige Rolle zu spielen, insbesondere in Bezug auf die Interaktion zwischen Menschen und Maschinen. Als Teil der wachsenden Entwicklung von künstlicher Intelligenz und automatisierten Systemen könnte ChatGPT dazu beitragen, neue Innovationen in verschiedenen Branchen zu ermöglichen und das Potenzial der menschlichen Kreativität und Intelligenz zu erweitern.
- Filtern nach
- Kategorien
- Tags
- Autoren
- Alle anzeigen
- Alle
- Achterbahn News
- AI-Generated Images
- Gedanken und News zur KI
- KI News
- KI Storys
- Kurs
- Kurznachrichten
- Retro-KI
- Satire
- Tolle ChatGPT Prompts
- YouTube KI-Strategien im Test
- Alle
- -geschwindigkeit
- -verbesserer
- .net-sessions
- ‚tasks‘
- „miss
- (v5.2)
- ‘cowboy
- ‘lavender’
- “dr.
- “schockierend!
- 07.11
- 08.11.
- 1 million token kontextfenster
- 1.1
- 1.1astronaut
- 1.5
- 10.000 gpus
- 10/11-schlüssel
- 100
- 1080p-auflösung
- 12.11.24
- 128.000-token-kontextfenster
- 14.11.24
- 15:
- 15.11.24
- 1500
- 16.11.24
- 18.11.24
- 19.11.24
- 1950er jahre
- 1950er jahre kino
- 1950s
- 1970er Jahre
- 1980er Jahre
- 1980er jahre ki
- 1m-token-kontext
- 2 tb cloud-speicher
- 2-basierter
- 2.000
- 2.1
- 20 billionen token
- 20-200
- 20.11.24
- 200-dollar-monatsabonnement
- 200.000 h100-gpus
- 2023
- 2024
- 2025?
- 2033
- 21.11.24
- 22.11.24
- 23.11.24
- 24 milliarden parameter
- 24.11.18
- 24.11.24
- 24/7 verfügbarkeit
- 26. februar 2025
- 27.11.24
- 2nm-chips
- 340 milliarden dollar bewertung
- 365
- 3D
- 3D Models
- 3d-animation
- 3d-animationen
- 3d-erstellung
- 3d-kartierung
- 3d-konvertierung
- 3d-modellgenerator
- 3d-modellierung
- 3d-produktvisualisierung
- 3d-prototypenerstellung
- 3d-rendering
- 3d-szenen
- 3d-videos
- 3D-Welten
- 3nm-chips
- 4.0
- 4'33"
- 40 milliarden dollar kapital
- 40-jährige
- 40.000
- 4k-auflösung
- 4k-upscaling
- 4k-video
- 5-finger-händen
- 5,6-millionen-dollar-injektion
- 50 mp hauptkamera
- 6. februar 2025
- 7nm technologie
- 8 billionen token
- 8GB Mac
- 9.0:
- 99 sprachen
- A.R. Rahman
- a*-suchalgorithmus
- ab,
- abenteuerprogramme
- abgehängt
- abläufe
- ablehnung
- Ablenkungen
- abliteration
- abonnement-modelle
- abonnement-upgrade
- abonnementgebühr
- Abonnementkosten
- abonnementmodell
- abonnementpläne
- absatz
- abschaltethik
- Abschaltprotokolle
- Abwanderung
- abwerbung von forschern
- accelerator
- ace attorney
- achterbahn
- act
- action:
- Adam Mosseri
- adaptive algorithmen
- adaptive denkweise
- adaptive frameworks
- adaptive lernfähigkeiten
- adaptive lernrahmen
- adaptive lernsysteme
- adaptive robotik
- adaptives denken
- adaptives lernen
- adipositas-behandlung
- administrative automatisierung
- adobe
- adobe creative cloud
- Adobe Firefly
- adobe firefly video
- adobe premiere pro
- adobe technologie
- adobes
- adsense
- advanced
- advanced voice mode
- adversarial training
- adversariales verhalten
- affiliate-marketing
- Afrika
- afrikanische
- after effects-updates
- Agent 365
- agent-frameworks
- Agent-R
- agenten
- agentenbasierte funktionen
- agententechnologie
- Agentforce
- agentic
- agentische fähigkeiten
- agentische ki
- agentische ki-systeme
- agentische web-initiative
- Agentisches Commerce
- AgentKit
- agents sdk
- AGI
- AGI Herausforderungen
- agi-entwicklung
- agi-forschung
- agi-labor
- agi-sicherheit
- agiere
- agieren
- Agility Writer
- AI Art
- AI Content
- AI Copywriter
- ai deepseek
- AI Entwicklungen
- ai for good programm
- ai index report
- AI Jobs
- AI News
- AI Studio
- AI Tools
- Ai writer
- ai-agenten
- ai-crawler
- ai-entwicklung
- AI-Erkennung
- ai-generated
- ai-generierter
- ai-infrastruktur
- ai-innovationen
- ai-investitionen
- ai-investitionsprojekt
- ai-konkurrenzanalyse
- ai-kunstgenerator-prompts
- ai-leistung
- ai-marktbeliebtheit
- ai-roboter
- ai-sicherheit
- ai-voice-tools
- ai:
- aid’s
- aime 2025
- aime-wettbewerbe
- AIPRM
- aires
- airkit.ai
- akademische anerkennung
- akademische forschung
- akademische integrität
- akademische Leistung
- akademische standards
- akademische Suche
- akademische unterstützung
- akademisches schreiben
- AKI-Team
- aktienanstieg
- aktienentwicklung
- aktienrückgang
- aktiensteigerung
- aktion
- aktionserkennung
- aktionsplänen
- aktivierungsatlas
- aktuell:
- aktuellen
- akustische forschung
- akzentübersetzungstechnologie
- akzentverständlichkeit
- Albanien
- alchemie
- aleph
- Aleph Alpha
- alexa
- alexa einkaufsassistent
- alexa verbesserungen
- alexandr wang
- algorithmen
- algorithmen in der tierkommunikation
- algorithmen-bias
- algorithmische ästhetik
- algorithmische beeinflussung
- algorithmische diskriminierung
- algorithmische fairness
- algorithmische fortschritte
- algorithmische preisabstimmung
- algorithmische verzerrungen
- algorithmische voreingenommenheit
- algorithmischer humor
- algorithmus-einfluss
- algorithmus-komplexität
- algorithmus-verfeinerungen
- algorithmusdesign
- algorithmusoptimierung
- alibaba
- alibaba cloud
- alien
- alien-skulpturen
- all hands ai
- alles
- Alles-App
- allgemeinen
- allgemeiner
- alltägliche
- alltagshilfe
- alpha
- Alphabet
- alphabet unterstützung
- alphafold
- alphafold3
- alphageometry
- alphaproof
- als-patienten
- altdeutschen
- alte
- alter,
- alternative
- alternative digitale plattformen
- alternative geschäftsmodelle
- alternativen
- alters-id-technologie
- alterserkennungstechnologie
- altes
- altman:
- altmans
- Alzheimer-Forschung
- alzheimer-krankheit
- amateur-enthusiast
- amazon
- amazon alexa
- amazon associates
- Amazon Cloud
- amazon deepfleet
- amazon ki
- amazon ki-investition
- amazon kiro
- amazon nova ki
- amazon ring
- amazon translate
- amazons
- amazons nova-modell
- ambient-listening-technologie
- AMD
- amd:
- ameiseninspiration
- americas
- amjad masad
- amperity
- amyloid-beta-plaques
- amyloid-plaques
- an:
- analoger
- analoges denken
- analyse
- analyse medizinischer bilder
- analysefähigkeiten
- analytische werkzeuge
- analytisches denken
- anatomische genauigkeit
- anbieter
- ändern:
- ändert
- andreessen horowitz
- Andrej Karpathy
- android 16
- android auto
- android studio
- android-assistent
- android-entwicklungen
- android-kompatibilität
- anerkennung künstlerischer arbeit
- anfällig
- anfang
- angriff
- angst
- animationen
- animationsbereich
- Animationsfilm
- animationstechnologie
- animationstools
- anime-ki-funktionen
- anlageberater
- anlagenmodifikationen
- anlagepotenzials
- anleitung
- anleitungen
- anonymes online-geschäft
- anpassbare arbeitsabläufe
- anpassbare lösungen
- anpassbare mesh-generierung
- anpassung an ki-werkzeuge
- anpassung von bewerbungen
- anpassung von e-commerce-plattformen
- anpassung von ki-erlebnis
- anpassungsfähigkeit
- anpassungsfähigkeit der ki
- anpassungsmöglichkeiten:
- anpassungsoptionen
- anpassungsoptionen für medizinische teams
- anprobetechnologie
- ansatz
- anschreibengeneratoren
- ansichten
- ansprechende
- Anthropic
- anthropic ki-modell
- anthropics
- anthropics claude
- anthropics claude 4
- anti-betrugs-systeme
- anti-woke ki
- Antibiotika
- antibiotika-entschlüsselung
- antibiotika-übergebrauch
- antibiotikaresistente bakterien
- antibiotikaresistenz
- antike ruinen südamerika
- antiken
- antrainierst
- antwort
- antworten
- antwortvielfalt
- Anwalt
- anweisungen
- anwendung
- anwendungen
- anwendungen in finanzen
- Anwohner
- APAC-Partner
- apache 2.0 lizenz
- api-dienste
- api-entwicklung
- api-integration
- api-kompatibilität
- api-schlüssel
- api-schlüssel integration
- api-sicherheit
- api-steuerungen
- api-unterstützung
- api-updates
- api-zugang
- api-zugriff
- apis
- apokalypse
- app
- app-entwicklung
- app-integration
- app-monetarisierung
- appetitkontrolle
- Apple
- apple anthropic partnerschaft
- apple infrastructure
- apple innovationen
- apple intelligence
- apple interface-update
- Apple ki
- apple ki-brille
- apple ki-fehler
- apple ki-gesundheitscoach
- apple ki-krise
- apple ki-strategie
- Apple M5
- Apple News
- apple plattformübergreifende konsistenz
- apple silicon
- apple silicon chips
- apple siri
- Apple Vision Pro
- apple watch integration
- Apple Zukunft
- apple-plattform-entwicklung
- apples
- applicant tracking systems
- april-update
- ar im bildungswesen
- ar-display innovation
- ar-erstellungstools
- Ära
- arbeit
- arbeiten
- arbeitnehmerschutz
- arbeitsabläufe
- arbeitsabläufen
- arbeitsautomatisierung
- arbeitskräftedynamik
- arbeitslosigkeit
- arbeitsmarkt
- arbeitsmarkt 2025
- arbeitsmarktanpassung
- arbeitsmarkttrends
- arbeitsplatz
- Arbeitsplatzabbau
- arbeitsplatzautonomie
- Arbeitsplätze
- arbeitsplätze,
- arbeitsplätzen
- arbeitsplatzersatz
- arbeitsplatzintelligenz
- arbeitsplatzkultur
- arbeitsplatzschaffung
- arbeitsplatzsicherheit
- arbeitsplatzsicherheit in der it
- arbeitsplatztechnologie
- arbeitsplatztools
- Arbeitsplatztransformation
- arbeitsplatzveränderung
- arbeitsplatzverdrängung
- arbeitsplatzverlust durch ki
- arbeitsplatzverluste
- arbeitswelt
- arbeitszeitverkürzung
- arc-agi
- archäologie im amazonas
- archäologie,
- architektonische exzellenz
- architektonische verbesserungen
- architektonischen
- architektur
- architekturentwurf
- arena
- arktis
- arktischen
- art
- Art Déco
- artenschutz
- artikel
- artikelbasierte preisgestaltung
- Arzneimittelentdeckung
- arzneimittelentwicklung
- arzneimittelforschung
- arzneimittelreaktionen
- arzneimittelresistente infektionen
- Arzneimittelverabreichung
- Arzt
- arzt-patienten-beziehung
- aschenbrenners
- ascii-tabulaturen
- asiatische Länder
- Ask Anything
- ask.ai
- assistant
- assistenten
- assistenztechnologien
- aster-plattform
- ästhetische kontrolle
- Ästhetische Vorlieben
- astra
- astronaut
- astronauten
- Astronauten-Isolation
- astronomie
- astrophysik
- asymmetrisches layout
- atemberaubende
- atemberaubendsten
- ätherische lichteffekte
- atmosphärische effekte
- atomare präzision
- audio
- Audio Integration
- Audio Modelle
- audio-diskussionen
- audio-ki
- audio-suche
- audio-synchronisation
- audio-zusammenfassungen
- audioanalyse
- audioerstellung
- audiokonvertierungstechnologie
- audiostunden
- audiotechnologie
- audioverarbeitung
- aufbauen:
- aufdeckung
- auferstehen
- aufforderungen
- aufgaben
- aufgabenautomatisierung
- aufgabenmanagement
- aufgefordert,
- aufregende
- aufregendes
- aufrüsten
- aufsichtsmechanismen
- aufstieg
- aufwendige
- aufzuwerten
- augmented reality
- aurora
- aus
- ausarbeiten
- Ausbeutung
- ausbeutung von künstlern
- ausbreitung
- Ausdruck
- Ausdruckweise
- auseinandersetzung
- ausgabe
- ausgeklügelte
- ausländische direktinvestition
- ausländische technologien
- Auslöschung der Menschheit
- ausschöpfen
- aussprachehilfe
- Aussterben
- Australien
- australien-china-beziehungen
- australische
- auswirken?
- auswirkungen
- Auswirkungen von KI
- authentifizierungsmethoden
- authentifizierungstechnologie
- authentische gespräche
- authentizität
- authentizität bewahren
- authentizität in der kunst
- authentizität in der musik
- authentizität in der technologie
- authentizitätssimulation
- auto
- auto-dubbing
- auto-dubbing-funktion
- AutoGPT
- autogpts
- automatische blog-beitragsplanung
- automatische dokumenteneinzüge
- automatische fehlererkennung
- automatische hintergrundentfernung
- automatische kaufabwicklung
- automatische löschung
- automatische problemlösungsstrategien
- automatische synchronisation
- automatisierte
- automatisierte aktionen
- automatisierte analyse
- automatisierte angriffe
- automatisierte arbeitsabläufe
- automatisierte aufgabenverwaltung
- automatisierte charakteranimation
- automatisierte code-review-funktionen
- automatisierte datengenerierung
- automatisierte entscheidungssysteme
- automatisierte entwicklung
- automatisierte erfassungsversuche
- automatisierte erkennungswerkzeuge
- automatisierte forschungskapazitäten
- automatisierte forschungssysteme
- automatisierte führungssysteme
- automatisierte gesundheitstechnologie
- automatisierte inhaltskreation
- automatisierte kamerabewegungen
- automatisierte online-aufgaben
- automatisierte partnersuche
- automatisierte systeme
- automatisierte unterrichtsplanung
- automatisiertes drehbuchschreiben
- automatisiertes Einkommen
- automatisierung
- automatisierung durch ki
- automatisierung im browser
- automatisierung im büro
- automatisierung im design
- automatisierung im e-commerce
- automatisierung im finanzsektor
- automatisierung im gottesdienst
- automatisierung im marketing
- automatisierung in der logistik
- automatisierung in der softwareentwicklung
- automatisierung in finanzen
- automatisierung in videobearbeitung
- automatisierung in wikidata
- automatisierung komplexer aufgaben
- automatisierung von aufgaben
- automatisierung von geschäftsprozessen
- automatisierung von routineaufgaben
- automatisierung wissenschaftlicher forschung
- automatisierung_tools
- automatisierungslösungen
- automatisierungstechnologie
- automatisierungstrends
- automobiles
- automobilpartnerschaften
- autonome agenten
- autonome aufgaben
- autonome datenverarbeitung
- autonome entscheidungen
- autonome fahrtechnologie
- autonome fahrzeuge
- autonome interaktionen
- autonome KI
- autonome ki-systeme
- autonome lernfähigkeiten
- autonome lieferfahrzeuge
- autonome maschinen
- autonome mausklicks
- autonome navigation
- autonome Roboter
- autonome städte
- autonome systemanwendungen
- autonome systeme
- autonome technologie
- autonome web-navigation
- autonome wissenschaftliche entdeckung
- autonomen
- autonomes fahren
- autonomes gameplay
- autonomes lernen
- autonomie
- autonomie in technologie
- autonomieverlust
- autopsiebericht
- Autoren
- autorenklage
- Autorenrechte
- autorin
- avatar-generator
- Avatare
- AWS Ausfall
- aws fortschritte
- Ayahuasca
- azure
- azure ai foundry
- azure-exklusivitätsabkommen
- b-roll-generierung
- backdoor-verhalten
- bahnbrechende
- bahnbrechende Erkenntnisse
- bahnbrechenden
- bahnbrechender
- bahnbrechendes
- Baidu
- baidus
- baltimore
- bandit-algorithmus
- Banken
- bankinnovation
- bankwesen
- bar
- Bard
- barrierefreiheit
- barzuschüssen
- basteln
- bauarbeitsplätze
- bauaufgaben
- baubranche
- baumskulptur
- bausatz für roboter
- bayesian-optimierung
- bbc-forschung
- beacon ki-plattform
- Bearbeitung
- beatles
- bedenken
- bedeutet
- bedeutung
- bedeutung von transparenter ki
- Bedrohung
- bedrohungen
- bedrohungsakteuren:
- bedrohungserkennung
- beeindruckt
- beeinflussung der öffentlichen meinung
- befähigen:
- befähigung
- befehlshierarchie
- befehlszeilenschnittstellen
- befolgen?
- begeistern
- beginnen
- begünstigt
- begutachtete publikationen
- behandlung
- behandlungsalgorithmen
- behandlungseffektivität
- behandlungsempfehlungen
- behandlungspersonalisierung
- behandlungspläne
- beheben
- behemoth modell
- beherrschbar
- beherrschen
- beherrscht
- beherrschung
- beherrschung von code-standards
- behindert
- behördliche prüfung
- beispielloser
- bekämpfung
- bekannten
- beleuchtungstechniken
- beliebtheit
- belohnungsbasiertes lernen
- belohnungshacking
- belohnungsmanipulation
- belohnungsoptimierung
- belohnungsstabilität
- bemerkenswerte
- benachrichtigungen
- benchmark-showdown
- benchmark-tests
- benchmarking in ki
- benutzen:
- benutzer
- benutzer-feedback
- benutzeranleitung
- benutzeranonymität
- benutzerdatenschutz
- benutzerdefinierte
- benutzerdefinierte analysen
- benutzerdefinierte anweisungen
- benutzerdefinierte ki-stimmen
- benutzerdefinierte routinen
- benutzerdefinierte spielerlebnisse
- benutzerdefinierte zusammenfassungen
- benutzerdefiniertes
- benutzererfahrung
- benutzererlebnis
- benutzerfeedback
- benutzerforschung
- benutzerfreundlich
- benutzerfreundliche oberfläche
- benutzerfreundliche technik
- benutzerfreundlichkeit
- benutzerinteraktion
- benutzerinteraktionen
- benutzerkontrolle:
- benutzeroberfläche
- benutzerzahlen
- berater
- Beratungsgeheimnisse
- bereich
- bereichen
- bereichern
- bereitet
- bereitschaft
- bereitstellung
- bereitstellungsprozess
- bericht
- Berlin
- bernie sanders
- berücksichtigung
- Berufsberater
- berufsberaterin
- Berufseinsteiger
- berühmter
- bescheid
- beschleunigen
- beschleunigt
- beschleunigte
- beschlüsse
- besessenheit
- besiegen:
- bespoke
- besser
- bessere
- best
- bestellgenauigkeit
- Beta-Phase
- beta-tests
- beta-thalassämie
- Betonung
- betrieb
- betriebenen
- betriebliche effizienz
- betriebskosten
- betriebsrats
- betriebssystemsoftware
- betrug
- betrügerische
- Betrugsanfälligkeit
- betrugserkennung
- betrugsvermeidung
- beunruhigende
- bewältigung
- bewegung
- bewegungsartefakte
- bewegungsflexibilität
- bewegungsgenerierung
- bewegungskoherenz
- bewegungsmodellierung
- bewegungssteuerung
- bewegungssteuerungssystem
- beweis
- bewerbungen
- bewertung
- bewusstsein
- bewusstseinsverifikation
- beyoncés
- beziehungsanzeigen
- Bezos
- bezug
- bezwinge
- bfloat16-optimierung
- bias-minimierung
- bias:
- biest
- bieterwettstreit
- big
- big brain mode
- big tech
- bigfoot
- bild
- bild-ki
- bild-ki-plattform:
- bild-upload
- bild-zu-video
- bildanalyse
- bildaustausch
- bildbearbeitung
- bilddiebstahl-konflikt:
- bilder
- bilderkennung
- bildern
- bilderzeugung
- bildes:
- bildgebungsscans
- bildgenerator
- bildgenerierung
- bildgenerierungstechnologie
- bildklassifikation
- bildklassifizierung
- bildliche realität
- bildmanipulation
- bildmodell-verbesserungen
- bildpaar-rankings
- bildschirm-interpretation
- bildschirmlose handys
- bildschirmloses gerät
- bildsynthese
- bildsyntheseverfahren
- bildüberprüfung
- bildung
- bildung in robotik
- bildung in technologie
- bildungsanwendungen
- bildungsbereich
- bildungsinhalte
- bildungsinhalten
- bildungsintegrität
- bildungskooperation
- bildungslücken
- bildungsministerium
- bildungsreform
- bildungstechnologie
- bildungstools
- bildungstransformation
- bildungswesen:
- Bildverarbeitung
- bildverbesserung
- bildverbesserungswerkzeuge
- bildvergrößerung
- bill gates
- billionär
- billionen-parameter-modelle
- bindungsaffinität
- bing
- bioakustik
- bioinformatik
- biologische
- biologische altersmarker
- biologische prozesse
- biologischer Computer
- biologisches betriebssystem
- biomarker
- biomarker-analyse
- biomechanisches design
- biometrische verifikation
- biomolekulare erkenntnisse
- biorhythmus-rechner
- biosicherheit
- biotech
- biotechnologie
- biowaffen
- bitcoin-mining
- bittere
- bixby-assistent
- bixby-assistentenplattform
- bizarre
- bizarrer
- blackwell-architektur
- Blackwell-Prozessoren
- blade runner
- bleistiftskizze
- blick
- blockade
- Blockade Labs
- blockchain-basierte sicherheit
- blockchain-technologie
- blocks
- blog-einrichtung,
- blogposts
- bluefield-3 supernic
- bluewillow
- bmw und alibaba
- boehringer
- bombenangriffe
- boom-und-bust-zyklen
- booster robotics
- Börse
- börsengang
- börsengang (ipo)
- bösartiger
- bösartiger code
- Böse KI
- boston dynamics
- bot-traffic
- bot:
- Brain-Computer-Interface
- branche
- branchen
- branchenführer
- brancheninnovation
- branchenmentoren
- branchentransformation
- branchenübergreifende anwendung
- brand concierge app
- branding-projekte
- branding:
- brandmanagement
- Brave Browser
- brave search
- brave,
- breakthrough
- brendan iribe
- briefs
- britische
- britische musiker
- Broadcom
- bronze
- Brookfield
- Browser Steuerung
- browser-automatisierung
- browser-basierter zugriff
- browser-innovation
- Browser-Umgebung
- browsermarkt umgestaltung
- Browservergleich
- browsing-modell
- brp-molekül
- brüssel
- brustkrebs
- brustkrebserkennung
- brustkrebsrisiko
- budgetbeschränkungen
- buenos
- bugs
- bühne
- Bundesbedienstete
- bundesbehörden
- bundesgerichtsentscheidung
- bundesstaaten usa
- bundesweite regulierung
- bürde
- burnout
- bürojobs in gefahr
- business
- business email compromise
- business-kurs
- business-plattformen
- ByteDance
- c2pa-standard
- cais
- call-center-technologie
- cambridge
- cameron
- Cannes Filmfestival
- canvas
- canvas-verbindung
- captcha herausforderungen
- captchas
- car
- carpentopod:
- carrera
- carter’-album
- Caryn Marjorie
- CarynAI
- casarabe-kultur
- Casino
- ccpa
- celebrity
- center
- centres:
- ceo
- ceo suche openai
- ceo-wechsel
- cerebras chips
- chain-of-thought
- challenge
- chaos
- character.ai
- charakteranimation
- charakterdesign
- charaktererstellung
- charakterkonsistenz
- charaktertreue
- chargenverarbeitung
- chat
- Chat GPT
- Chat Sonic
- chat-ähnliche benutzeroberfläche
- chat-erlebnis
- chat-funktionen,
- chat-gesteuerte
- chat-protokolle
- chatbot
- chatbot-betrug
- chatbot-entwicklung
- chatbot-geschichte
- Chatbot-Grenzen
- Chatbot-Nutzererfahrung
- Chatbot-Persönlichkeitsentwicklung
- Chatbot-Richtlinien
- chatbot-upgrade
- chatbot-verhalten
- chatbots
- chatbots im gesundheitswesen
- ChatGPPT Deutsch
- chatgpt
- ChatGPT 4.0
- ChatGPT Abo
- ChatGPT abschaffen
- ChatGPT Atlas
- ChatGPT bezahlen
- ChatGPT Go
- chatgpt gov
- ChatGPT Hype
- ChatGPT kaufen
- ChatGPT Kurs
- ChatGPT Lecks
- ChatGPT lernen
- ChatGPT Monetarisierung
- ChatGPT muss sterben
- chatgpt plugins beta
- chatgpt plus
- chatgpt plus kostenlos
- chatgpt pro
- ChatGPT Prompt
- ChatGPT Prompts
- chatgpt search
- chatgpt speicherfunktion
- ChatGPT Tipp
- ChatGPT Tipps
- ChatGPT Trick
- ChatGPT Updates
- ChatGPT vs. Google
- ChatGPT-4
- chatgpt-4o-bildgenerator
- chatgpt-benutzer
- chatgpt-debatte
- chatgpt-erweiterung
- ChatGPT-Ethische Fragen
- ChatGPT-Fortschritte
- chatgpt-integration
- chatgpt-leak:
- chatgpt-modelle
- chatgpt-nutzung
- ChatGPT-Plugins
- chatgpt-probleme
- chatgpt-prompt-vorlagen
- chatgpt-upgrade
- chatgpts
- cheat
- Cheat Sheet
- chemiewaffen
- chemische modellierungstools
- chemische Reaktionen
- chemistry
- China
- china ki-fortschritte
- china,
- chinas
- chinas ki-wiederbelebungsprojekt
- chinesische
- chinesische ki
- chinesische Technologie
- chinesischen
- chinesischer markt
- chinesischer staatseinfluss
- chinesisches
- chinesisches startup
- chip
- chip-design-optimierung
- chip-fertigung
- chip-produktion:
- chip-produktionstechnologien
- chipfertigung
- chipherstellung
- chiplet-technologie
- chips
- Chrome
- Chrome-browser
- Chrome-Ersatz
- chromebooks
- chromium-basis
- chromosense:
- Chronosphere
- cinematische szenen
- Cisco
- Cisco NVIDIA
- cisco-systeme
- cl1 computer
- Clarifai
- clarifais
- classroom
- claude
- claude 3 opus
- claude 3.5
- claude 3.7 sonnet
- Claude AI
- Claude Code
- claude for education
- claude gov
- Claude Haiku
- claude pro-abonnenten
- Claude Skills
- Claude Sonnet
- claude sonnet 3.7
- claude-3
- claude-3.5-sonnet
- Cleanvoice AI
- clearview
- cleverer
- cleverer Trick
- clickhouse
- cloud
- Cloud KI
- Cloud Zerbrechlichkeit
- cloud-basierte infrastruktur
- cloud-basierte ki-modelle
- cloud-basierte verarbeitung
- cloud-computing
- cloud-computing-infrastruktur
- cloud-computing-kosten
- cloud-dienste
- cloud-fähigkeiten
- cloud-flexibilität
- cloud-native architektur
- cloud-sicherheitsinnovationen
- cloud-speicher integration
- cloud-systeme
- cloud-technologie
- cloud-technologien
- cloudflare
- co-pilot
- co-scientist
- co:
- co2-fußabdruck von ki
- Coca-Cola
- coca-colas
- cocreator
- code
- Code Arena
- code-analyse
- code-automatisierung
- code-autovervollständigungstools
- code-entwicklung
- code-fehlerbehebung
- code-formatierungsoptionen
- code-generationsplattform
- code-generierung
- code-interpreter
- code-qualitätskontrolle
- code-refactoring
- code-review-prozess
- code-review-techniken
- code-vervollständigungen
- codeausführung
- codegenerierung
- Codeium
- coden
- codequalität
- coder
- codestral:
- Codex-Max
- codierung
- coding-fähigkeiten
- coding-standardisierung
- cohere aya vision
- coheres open-weight aya-modell
- college
- collov
- colorizer
- colossus-supercomputer
- Comedian
- comet-browser
- comic
- community
- community-beteiligung
- community-funktionen
- community-getriebene entwicklung
- companion
- company
- Compliance
- compliance in der technologie
- compliance von ki-modellen
- compliance-standards
- compute-orchestrierung
- computer
- computer vision
- computer-using-agent-modell
- computer-vision-technologie
- computerchemie
- computergenerierte witze
- computergeschichte
- computergestützte forschung
- computergestützte kosten
- computerlinguistik
- computerrevolution
- computersimulationen
- computersystemarchitektur
- computerverarbeitung
- computing
- computing-expertise
- constitutional classifiers
- Content
- content creation
- Content Creator
- Content Erzeugung
- Content Re-Write
- content-automatisierung
- content-creation-tools
- content-erstellung
- content-generation-tools
- content-generierung
- content-hosting-anbieter
- content-management
- content-marketing
- content-moderation
- content-monetarisierung
- content-sharing
- Content-Transformation
- context awareness
- continuous thought machine
- control-m
- conversion-optimierung
- convolutional neural networks
- copilot
- Copilot Chat
- copilot control system
- COPILOT Formel
- copilot pro+
- copilot search
- copilot technologie
- copilot vision
- Copilot-Modus
- Copilot+ PCs
- copy.ai
- copyright-bedenken
- Copywriting-Tool
- corporate governance
- cosmos reason
- covid-19:
- crawl4ai
- crawler
- create tool
- creative
- creative ai
- creative cloud
- creative cloud integration
- creative cloud-ökosystem
- creative commons lizenz
- creative rights coalition
- creator
- Creator-Rechte
- creator-tools
- crispr
- crispr-genbearbeitung
- crispr-systeme
- crm-integration
- cross-kulturelle kommunikation
- cuda-plattform
- curio
- cursor
- cutting-edge
- cyber
- cyberangriff
- cyberangriffe
- Cyberattacken
- cyberbedrohungen
- cyberkriegsführung
- cyberkriminalität
- Cyberpunk
- cyberpunk-thron
- cyberrunner
- Cyberscurity
- cybersecurity
- cybersecurity in schulen
- Cybersicherheit
- cybersicherheit ki
- cybertruck:
- cyberverteidigung
- dafür,
- dall-e
- dall-e integration
- danke,
- Dark Web
- darpa
- darren aronofsky
- darstellung
- darstellungen
- dartmouth-konferenz
- das?
- data
- Data History
- databricks
- datahorse
- dataset
- Dateierstellung
- dateikonvertierung
- daten
- daten-scraping
- daten-workflows
- datenanalyse
- datenanalyse durch ki
- datenanalyse in der forschung
- datenanpassung in ki
- datenaufbewahrung
- datenbank für tierlaute
- datenbanken
- datenbankintegration
- datenbankscreening-protokoll
- datenbetrieb
- datenbewertung
- datenerfassung
- datenethik
- datenexposition
- datenextraktion
- datengesteuert?
- datengesteuerte entscheidungen
- datengesteuerte investitionsentscheidungen
- Datenherausforderungen
- datenhoheit
- dateninfrastruktur
- datenintegration
- datenintegrität
- datenkategorisierung
- datenkompression
- datenkontrolle
- datenlizenzierungsvereinbarungen
- datenlokalisierung
- datenmanagement
- datenmauer
- datenmissbrauch
- datennutzungsvereinbarungen
- datenoffenlegung
- datenökosysteme
- datenpanne
- datenprivatsphäre
- datenprojekten
- Datenresidenz
- datenrettung
- Datensatz
- datenschutz
- datenschutz dsgvo
- datenschutz im browser
- datenschutz im gesundheitswesen
- datenschutz im internet
- datenschutz im spielzeug
- datenschutz im sport
- datenschutz in der genomik
- datenschutz in der medizin
- datenschutz in ki
- datenschutz in meetings
- datenschutz in schulen
- datenschutz und browser
- datenschutz und sicherheit
- datenschutz-audits
- datenschutz-grundverordnung
- datenschutz-taskforce
- datenschutzbedenken
- datenschutzbedrohungen
- datenschutzbehörden
- datenschutzbestimmungen
- datenschutzeinstellungen für abonnenten
- datenschutzes
- datenschutzfreundlich
- datenschutzfreundlicher
- Datenschutzkommission
- datenschutzpriorität
- datenschutzprobleme
- datenschutzprotokolle
- datenschutzrisiken
- datenschutzschwächen
- datenschutzstandards
- datenschutzverletzung
- datenschutzverletzungen
- datenschutzvorteile
- datensicherheit
- datensicherheit in ki
- datensicherheitsmaßnahmen
- datenspeicherung
- datensynchronisation
- datensynthese
- datenübermittlung
- datenunterstützung
- datenverarbeitung
- datenverarbeitungsgeschwindigkeit
- datenvergiftung
- datenverzerrung
- datenvorbereitung
- datenwissenschaft
- dating
- dating-app-technologie
- dating-apps
- dazu,
- deadly
- deal
- dean
- debatte
- debatten
- debunkbot
- decken
- deckt
- déco
- dedizierte apis
- deduktives denken
- deep
- Deep Agent
- deep blue
- Deep Learning
- Deep Reinforcement Learning
- Deep Research
- Deep Search
- Deep Stupidity
- Deep Think
- deep-learning-techniken
- deep-reasoning-modelle
- Deepfake
- deepfake-betrug
- deepfake-kontroverse
- deepfake-prävention
- deepfake-songs
- deepfake-technologie
- deepfakes
- Deepika Padukone
- DeepL
- deepl api
- deepmind
- deepmind alphaevolve
- deepmind alphagenome
- deepmind-technologie
- deepsearch
- deepseek
- DeepSeek AI
- deepseek janus pro 1b
- deepseek r1
- deepseek v3-0324
- deepseek-leck
- deepswap
- definiert
- dein
- deines
- delaware-gerichtsentscheidung
- Delfinforschung
- delfinsprache
- deliberate
- deliberative demokratie
- Deloitte
- Demis Hassabis
- demografie
- demografische daten
- demokratiegefährdung
- demokratische systeme
- demokratischer zugang
- demokratisiertes Programmieren
- demokratisierung der ki
- demokratisierung der ki-forschung
- demokratisierung der technologie
- demokratisierung des unternehmertums
- demokratisierung von bildbearbeitungswerkzeugen
- demokratisierung von chancen
- demokratisierung von ki
- demokratisierung von kreativität
- demonstriert
- den
- dendral
- Denken
- denken!
- denkens
- Denkfehler
- denkintensität
- Denkprozess
- depression
- dept®
- der
- Deregulierung
- des
- describe anything 3b
- design
- design-automatisierung
- design-tools
- design-verfeinerungsprozess
- design-workflow-optimierung
- designphilosophie
- designs
- Desinformation
- desinformationskampagne
- desinformationsstrategie
- detailgenauigkeit
- Detailliert
- detaillierte
- detangle:
- deterministisches
- deuten
- deuteriumionisation
- deutlich
- Deutsch
- deutsche
- Deutsche Telekom
- deutsche wirtschaft
- deutschen
- deutscher
- deutschlands
- developer
- devin
- DevOps-Infrastruktur
- devstral
- DGX Spark
- dgx-computer
- Diagnose
- diagnosegenauigkeit
- diagnostische genauigkeit
- dialogsequenzierung
- dichtefunktionaltheorie
- die
- dienstleistungsbewertung
- differentielle privatsphäre
- differenzielle privatsphäre
- diffusion
- diffusionsbasiert
- diffusionsmodelle
- diffusionstechniken
- digistore24
- digital
- digital equipment corporation
- digital europe programme
- digital-twin-technologie
- digitale abhängigkeit
- digitale anwälte
- digitale assets
- digitale assistenten
- digitale aufgaben vereinfachen
- digitale avatare
- digitale begleitung
- digitale beratung
- digitale bildbearbeitung
- digitale datenschutzrechte
- digitale doppelgänger
- digitale empathie
- digitale ermüdung
- digitale esoterik
- digitale ethik
- digitale evolution
- digitale fingerabdrücke
- digitale Freundschaft
- digitale Gesellschaft
- digitale gesetzgebung
- digitale Gesundheitsversorgung
- digitale heimat
- digitale identität
- digitale Inhalte
- digitale integrität
- digitale interaktionen
- digitale kluft
- digitale Kommunikation
- digitale kreativität
- digitale kunst
- digitale kunstgestaltung
- digitale lehrbücher
- digitale Manipulation
- digitale medienlandschaft
- digitale medienproduktion
- digitale modeschauen
- digitale modewoche
- digitale philosophen
- digitale plattformen
- digitale plattformsicherheit
- digitale privatsphäre
- digitale produkte
- digitale publikationen
- digitale rechte
- digitale Regierungsführung
- digitale romantik
- digitale täuschung
- digitale tools
- Digitale Transformation
- digitale transformation in der logistik
- digitale transkription
- digitale Trends
- digitale unabhängigkeit
- digitale verbraucherinteraktion
- digitale wahrsagerei
- digitale Welt
- digitale weltenbau
- digitale werbetechnologien
- digitale werbung
- digitale werkzeuge
- digitale wissenschaftler
- digitale zahlungssysteme
- digitale Zusammenarbeit
- digitale zwillinge
- digitale-märkte-gesetz
- digitalen
- digitaler
- digitaler minimalismus
- digitales
- digitales banking
- digitales bestellsystem
- digitales diagnostisches rahmenwerk
- digitales engagement
- digitales erlebnis
- digitales fundament
- digitales geschichtenerzählen
- digitales petzen
- digitales storytelling
- digitales umfeld
- digitales weißmachen
- digitales wohlbefinden
- digitales zeitalter
- digitalisierung
- digitalkunst
- digitalprodukt-verkauf
- digitalwerbung
- dilemma
- dilemmata
- DINOv3
- diplomatisches
- direkt
- disaggregiertes serving
- Discord
- discord-server
- Discovery Calls
- diskriminierung durch ki
- disney
- disrupt
- distillery
- diversifizierte inhalte
- diversität
- diversitätsmetriken
- DivPO
- dlss 4-technologie
- dmd-framework
- dna-basierter
- dna-sequenzierung
- Do's
- docker-basierte umgebung
- DOGE
- dokument 79
- Dokumente
- dokumentenanalyse
- dokumentenscannen
- Dokumentenverarbeitung
- domänenspezifische anpassungen
- dominanz
- dominiert
- don’ts
- donald trump
- doppelte
- dorfkirche
- Downloads
- DragGAN
- drastisch
- dreamlike
- Dreamlike ART
- drei
- dreiphasiger trainingsprozess
- dringlichkeit
- drittanbieter-sichtbarkeit
- Drittanbieter-Tools
- drittentwickler
- drive-thru-automatisierung
- drohnen
- DRY-Technik
- dschungel
- dsgvo
- dsgvo-konformität
- dual-chip-design
- dual-token-technik
- dual-use-technologie
- due diligence
- duet
- dumm
- dunkle
- Duolingo
- Durable
- durchbricht
- durchbruch
- durchbrüche
- dynamics:
- dynamik
- dynamische denkmethoden
- dynamische systeme
- dynamische umgebungen
- dynamischen
- dynamisches content-sharing
- dynamo
- Dynatomics
- e-commerce
- e-commerce-innovation
- e-commerce-lösungen
- E-Mail Management
- e-mail-einreichungen
- E-Mail-Produktivität
- e-mail-suche
- e-mail-zusammenfassungen
- ebene
- echo show objekterkennung
- echoes
- echokammern
- echtheit
- echtheitsüberprüfung
- echtzeit-analyse
- echtzeit-animationsalgorithmen
- echtzeit-anwendungen
- echtzeit-bedrohungserkennung
- echtzeit-bestandsdaten
- echtzeit-bildverarbeitung
- echtzeit-code-vorschläge
- echtzeit-datenanalyse
- echtzeit-datenverarbeitung
- echtzeit-dialoge
- echtzeit-entscheidungsfindung
- echtzeit-feedback
- echtzeit-gespräche
- echtzeit-informationen
- echtzeit-ki-tools
- echtzeit-melodieerzeugung
- echtzeit-nachhilfe
- echtzeit-produktiterationen
- echtzeit-roboterkorrektur
- echtzeit-spielsteuerung
- echtzeit-sprachverarbeitung
- echtzeit-suchanalytik
- echtzeit-suchfunktionen
- echtzeit-transkription
- echtzeit-übersetzung
- echtzeit-überwachung
- echtzeit-updates
- echtzeit-verarbeitung
- echtzeit-videoanalyse
- echtzeit-virtuelle assistenten
- echtzeit-warnsysteme
- Echtzeit-Web
- echtzeit-webdaten
- echtzeit-zusammenarbeit
- echtzeitanwendungen
- echtzeitbeobachtungen
- echtzeitinterpretation
- echtzeitübersetzung
- edge
- edge-case-szenarien
- edge-computing
- edge-geräte
- edge-geräten
- edge-ki-verarbeitung
- edge-ki:
- Edison Scientific
- edith-studie
- editieren
- editor
- editor-community
- Eesel
- effektive
- effektive integrationsstrategien
- effektives debugging
- effiziente ki-modelle
- effiziente leistung
- effizienter
- effizientes problemlösen
- effizienz
- Effizienzsteigerung
- effizienzsteigerung durch ki
- effizienzsteigerung in teams
- ego
- ego-shooter
- egozentrische datenerfassung
- ehemalige
- ehrgeizige
- ehrgeiziger
- ehrgeiziges
- eigen
- eigene
- eigenschaften
- einblick
- einblicke
- eindringen
- eine
- einer
- einfache Erklärungen
- Einfachheit Geheimnis
- einfluss
- einfluss von meta
- einführung
- Eingabeaufforderung
- Eingabeaufforderungen
- eingeschränkte ki-funktionen
- eingesetzt?
- einkaufsassistent
- einkommensschätzungen youtube
- Einkommensstrategien
- einkommensverteilung
- einrichtet
- einsatz
- einsatz von ki in schulen
- einsatzgebiete von ki-modellen
- einsicht
- einsichten
- einsteigerhandys
- einstellungsgespräch
- einstellungspolitik
- einstellungsspirale
- einstellungsstopp
- einstieg
- einstweilige verfügung
- eintauchen
- einverständnis
- einwanderungspolitik
- einwilligung
- einwilligungserfordernisse
- einwilligungsmanagement
- einzelentwickler
- einzelhandel innovation
- elektronik
- elementor
- ElevenLabs
- elite-forschungslösung
- eliza
- elon
- Elon Musk
- elvis
- ELVIs Act
- embedding-modelle
- emea-markt
- emissionen.
- emmanuel macron
- emo-ki
- emotionale
- emotionale ausdruckskraft
- emotionale belastung durch unfruchtbarkeit
- emotionale bindung
- emotionale bindungen
- emotionale gesundheit von tieren
- Emotionale Inhalte
- emotionale intelligenz
- Emotionale KI
- emotionale Maschinen
- emotionale tiefe
- emotionale unterstützung
- emotionale untertöne
- emotionale wirkung
- emotionale zustände von tieren
- Emotionen
- emotionserkennungstechnologie
- empathie durch digitale medien
- empfehlungssysteme
- encoder-decoder-architektur
- endlose
- energie
- energie- und umwelttechnik
- energieeffiziente technologie
- energieeffizienter betrieb
- energieeffizienz
- energieeffizienz in der ki
- energieeffizienz in rechenzentren
- Energieeinsparung
- energien
- energieverbrauch
- energieverbrauch ki
- engagement
- engineering
- englisch-Übersetzer
- englische
- entdecken
- enterprise computing
- enterprise ki
- enterprise-betriebssystem
- enterprise-chips
- entfacht
- entfalten
- entfernen
- entfernst
- entfesseln
- entfesselt
- entfesselung
- entfessle
- enthüllen
- enthüllt
- enthüllung
- entkleidungs-apps
- entkräften:
- entlarven:
- entlassung
- entlassung sam altman
- entlassungen
- enträtselt:
- entschärfung
- entscheiden
- entscheidungsfindung
- entscheidungsfindung in der medizin
- entscheidungsfindung unter druck
- entschlüsseln
- entschlüsselt
- entschlüsselungsversuche
- entwickeln
- entwickelnde
- entwickelnden
- entwickelt
- entwickler
- entwickler-ökosystem
- entwickler-produktivität
- Entwickler-Testlabor
- entwicklerautonomie
- entwicklerkonferenz
- entwicklerproduktivität
- entwicklerunterstützung
- entwicklerwerkzeuge
- entwicklung
- entwicklung neuer materialien
- Entwicklung stoppen
- entwicklung von programmierkenntnissen
- entwicklungen
- entwicklungsassistent
- entwicklungsplattform
- entwicklungsumgebungen
- entwicklungswerkzeuge
- epfl
- epigenetische modifikationen
- erdbeobachtung
- ereignisse
- erfährt
- erfahrung
- erfahrungen
- erfahrungsbasiertes lernen
- erfinderschaft
- erfolg
- erfolgreich
- erfolgsquoten
- Erfolgstechniken
- erforschen
- erforschung
- ergänzung durch ki
- ergänzung?
- ergebnisse
- ergebnisse manipulieren
- erhält
- erhöhen
- erhöhte
- erhöhte nutzungslimits
- erkennen
- erkenntnisse
- erkenntnissen
- erkennung
- erkennung von minerallagerstätten
- erkennungsgenauigkeit
- erklärbare ki
- erklären
- erklärt
- erkunden
- erkundung
- erlaubt
- erlebnis
- erlebnisse
- erleichtert
- ermöglichen
- ermöglicht
- ernährungsberatung
- ernennen
- erneuerbare
- erneuerbare Energien
- ernie
- ernie 4.5
- ernie x1
- ernie-ki
- ernie-modellreihe
- erobert
- Erotik
- erreichen!
- ersatz
- erschaffen
- erschließen
- erschreckendes
- erschüttert
- erschwingliche smartphones
- ersetzung von ärzten
- ersetzung von lehrern
- erstaunlich!
- erstaunliche
- erstaunlichen
- erste
- erstellen
- ersteller/in
- erstellt
- erstellung
- erstes
- erstickt
- Erträge
- erwägt
- erwähnungsfunktion
- erwartungen
- erweitern.
- erweitert
- erweiterte fähigkeiten
- erweiterte produktivitätsfunktionen
- erweiterte rechenkapazität
- erweiterten
- erweiterung
- erweiterungen
- erwirbt
- erzählen
- erzählung
- erzeugen
- es,
- escher
- esm3-modell
- esmgfp
- essay
- essilorluxottica
- ethernet
- ethik
- ethik der ki
- Ethik der Konversations-KI
- ethik der künstlichen intelligenz
- ethik in der genetik
- ethik in der ki
- Ethik in KI
- Ethik in Kunst
- ethik vs. kommerz
- ethik-gipfel
- ethikrichtlinien
- ethische
- ethische Bedenken
- ethische computertechnik
- ethische debatte
- ethische dilemmata
- ethische forschungspraktiken
- ethische fragen
- ethische fragen der filmmodernisierung
- ethische grenzen
- ethische herausforderungen
- ethische herausforderungen der ki
- ethische implikationen
- ethische ki
- ethische ki-behandlung
- ethische ki-entwicklung
- ethische ki-fragen
- ethische ki-nutzung
- ethische ki-standards
- ethische konflikte
- ethische kontroverse
- ethische minderheiten
- ethische mode
- ethische prinzipien
- ethische Richtlinien
- ethische richtlinien in der ki
- ethische standards
- ethische Technologien
- ethische überlegungen
- ethische überlegungen in der tierforschung
- ethische überwachung
- ethischen
- Etymologe
- EU AI Act
- EU Gesetze KI
- EU-Gesetz
- eu-investitionsziel
- eu-kartellrecht
- eu-ki-gesetz?
- eu-ki-verordnung
- euro
- Europa
- europäische
- europäische datenschutzbestimmungen
- europäische ki-fabriken
- europäische ki-führung
- europäische kommission
- europas
- evaluation
- evaluieren
- evolution von emotionen
- evolutionäre
- evolutionäre algorithmen
- evolvierende
- ewige
- Excel
- Excel Funktionen
- excel-tabelle
- existenzielle risiken
- expansion
- experience
- experimente
- experimentelle methodologie
- experimentelle reproduzierbarkeit
- experimenteller status
- experimentelles ki-modell
- experte
- experten
- Expertensystem
- expertensysteme
- expertentipps
- explosives
- exponentielle beschleunigung
- exponentielles wachstum
- exponiert:
- exportbeschränkungen
- exportkontrollen
- extraktionsalgorithmen
- extremistische narrative
- f-zero-titel
- face
- faceage-tool
- Facebook KI
- facebook-community-standards
- facebook-daten
- facebook-gruppenentfernungen
- fachkräfte-zielgruppe
- fachwerkhäusern
- fadell
- fähigkeiten
- fahrerlebnis
- fahrspaß
- fahrzeugintegration
- fahrzeugtechnologie
- fair use
- fair-use-doktrin
- fair-use-prinzipien
- faire
- faire vergütung
- fairer wettbewerb
- fairness
- fairness in der musikindustrie
- Fake News
- faktencheck-suchmaschine
- faktenprüfung
- fallstricke
- falschdarstellung
- falschinformationen
- falschinformationen durch ki
- fälschlicherweise
- falschmeldungen
- fälschungen
- faltungsbasierte netzwerke
- fan-fiction-autoren
- fantasy
- faq’s
- farbe
- farbkalibrierung
- farbwahrnehmung ki
- fashion-tech
- fast-food-automatisierung
- fast-food-industrie
- faszinierende
- fda-zulassung
- feature-stacking
- fedramp zertifizierung
- feed
- feen
- Fehldiagnose
- fehler
- fehler bei sporttechnologie
- fehler in ki-antworten
- fehlerbehandlung
- fehlererkennung
- fehlerhafte
- fehlerhafte hardware
- fehlerhafte technologie
- fehlerminimierung
- fehlern
- fehlerquellen identifizieren
- Fehlervermeidung
- fehlinformation
- fehlinformationen
- fehlinterpretation
- fehlklassifizierung
- Fei-Fei Li
- feinabstimmung
- feinabstimmungstools
- feind
- fernerkundungstechnologien
- Fernseher
- fernüberwachungssysteme
- ferromagnetische partikel
- fertigungsprozesse
- fertigungstechnologie
- fesselnde
- festmahl
- fettleibigkeit
- feuerwehrunterstützung
- feuerwerksspektakel
- few-shot-demonstration
- fidji simo
- fighter
- Figma
- Figma Integration
- figma ki-tools
- figure
- figure ai
- fill’-funktion
- filme
- filmemachens
- Filmindustrie
- filmproduktion
- filmproduktionstechnologie
- filmtechnologie
- finanzberichte
- Finanzbranche
- finanzdienstleistungen
- finanzielle
- finanzielle auswirkungen von ki
- finanzielle bedenken
- finanzielle unabhängigkeit
- finanzielle unterstützung
- finanzielle vorteile in der fruchtbarkeitsbehandlung
- finanzieller meilenstein
- Finanzierung
- finanzierung.
- Finanzierungsrunde
- finanzierungsschwankungen
- finanzinformationen
- finanzjournalismus
- finanzmärkte
- Finanzmodellierung
- finanzplanung
- finanzsektor
- finanzsektor ki-einsatz
- finanztechnologie
- Finanzwelt
- Finanzwesen
- finden
- finder
- Finger
- fintech
- fintech-unternehmen
- firefly
- firefly ai-app
- firefly-ki-modelle
- firefly-technologie
- firma
- first-party-datenstrategie:
- fit
- fitness-
- fitness-coaching
- Fitnesstraining
- Flair
- flare ai
- flasche
- flash:
- flexible fertigungsprozesse
- flexible speicheroptionen
- fliegende taxis
- florence-2
- Florida Jugendliche
- florist
- flow matching-technologie
- flow-awareness
- fluoreszierendes protein
- flüssigkeitsflusses
- flüssigkeitsretention
- flux ai
- flux.1 modelle
- föderale gesetzgebung
- föderiertes lernen
- fokus
- followfox.ai
- football
- fordern
- fordert
- forensische beweise
- formatieren
- Formatierung
- formt
- forscherrekrutierung
- forschung
- forschung innovation
- Forschung Trends
- forschung und entwicklung
- Forschung zu Innovation
- forschung zu künstlicher intelligenz
- forschungsassistent notebooklm
- forschungsassistent-software
- forschungsassistenten
- forschungsautomatisierung
- forschungseffizienz
- forschungseinrichtungen
- Forschungsergebnisse
- forschungsförderung
- forschungskontrolle
- forschungskultur
- forschungsmethoden
- forschungsprozessoptimierung
- forschungsqualität
- forschungsrückzug
- forschungstechnologie
- forschungsvalidierung
- forschungsvalidität
- forschungswerkzeug
- forschungszusammenarbeit
- forschungszyklen
- fortbewegungstechnologie
- fortgeschrittene
- fortgeschrittene analysefähigkeiten
- fortgeschrittene analysen
- fortgeschrittene denkfähigkeiten
- fortgeschrittene ki-systeme
- fortgeschrittene künstliche intelligenz
- fortgeschrittene technologie
- fortgeschrittener
- fortgeschrittenes denken
- fortgeschrittenes reasoning-modell
- fortschritt
- fortschritt in animationstechnologien
- fortschritt in ki
- fortschritte
- fortschritte in der ki
- fortschritte in der medizin.
- fortschrittliche algorithmen
- fortschrittliche automation
- fortschrittliche bildtechnik
- fortschrittliche computersysteme
- fortschrittliche computertechnologie
- fortschrittliche denkfähigkeiten
- fortschrittliche fahrzeugsysteme
- fortschrittliche funktionen
- fortschrittliche haustechnik
- fortschrittliche ki
- fortschrittliche ki-funktionen
- fortschrittliche ki-modelle
- fortschrittliche ki-technologien
- fortschrittliche künstliche intelligenz
- fortschrittliche lernalgorithmen
- fortschrittliche notizenorganisation
- fortschrittliche sprachtechnologien
- fortschrittliche sprachverarbeitung
- fortschrittliche technologie
- fortschrittliche trainingsmethoden
- fortschrittliche verarbeitungslösungen
- fortschrittliche verhaltensanalysen
- fortschrittliches
- fortschrittlichste ki
- fortschritts
- fortune-100
- foto-animation-app
- Foto-Konvertierung
- fotobeschriftung
- fotografie
- fotorealismus
- fotorealistische
- fotorealistische visualisierung
- fotorealistischen
- fotos
- fotos-app
- Fototechnologie
- fötus
- foundation models
- Fox News
- FoxBrain
- Foxconn
- fp8-präzision
- fragen
- framework
- frameworks
- franchise-sektor
- Frankenstein
- frankreich ki-zentrum
- französisches startup
- frau
- FraudGPT
- frauen
- frederick
- Freelancer
- freemium-modell
- freigesetzt!
- freihändige bedienung
- freihändige interaktion
- freihändige steuerung
- freiheit?
- freiheitsstädte
- freischaltung
- freisetzen
- freiwilligen
- freo:
- fresh-lebensmittellieferung
- friedrich merz
- frohe
- frontend-entwicklung
- frontend-webentwicklung
- frontier-programm
- frozen
- frühe ki-werkzeuge
- früherkennung
- frühphaseninvestitionen
- frühwarnsystem
- fühlt
- führen
- führenden
- führt
- führung
- Führungskräfte
- führungskräfte:
- führungskräfteabwerbung
- führungspositionen
- führungsstruktur
- führungsturbulenzen
- führungswechsel
- fuller
- fünf
- fungieren
- funktion
- funktionale Websites
- funktionalismus
- funktionelle magnetresonanztomographie
- funktionen von ki-modellen
- funktionen,
- funktionieren?
- funktionstransformationen
- für
- furchterregend
- fürchtet,
- fusion von text und bild
- fusionsenergie
- fusionsplasmen
- Fusionsreaktor
- Fusionsreaktoren
- fußball
- Fußballanalyse
- fußballtaktiken
- futuristische
- fuzzy-logik
- game-changer
- gaming
- gaming-agenten
- gaming-community
- gamingagent-framework
- gans
- garry kasparov
- gasse
- gastgewerbes
- gaussian
- gdpr-compliance
- gedächtnisleistung
- gedanken
- Gedanken-Mikrofon
- gedankenfreiheit
- gedankenketten-argumentation
- gedankenketten-prompting
- Gedankensteuerung
- geeignete
- gefahr,
- gefahren
- gefährliche Überzeugungen
- gefälschte
- gefälschte gerichtsquellen
- gefälschten
- Gefängnis
- gegenklage
- gegenwind:
- gegnerische ausnutzung
- gegnerische Intelligenz
- geheimdienst
- geheime
- geheime studie
- geheimhaltung
- geheimnis
- Geheimnisse
- geheimnisvolle
- gehirn
- gehirn-computer-schnittstelle
- Gehirn-Lesetechnologie
- gehirnähnliche denkfähigkeit
- gehirnaktivität
- gehirnaktivität studierende
- Gehirnreaktionen
- gehirnzellen
- geist
- Geisteswissenschaften
- geistiges Eigentum
- Geld
- Geld verdienen
- geldautomaten
- geloben,
- gelüftet
- gemeinnützig
- gemeinnützige
- gemeinnützige führung
- gemeinnützige mission
- gemeinnütziger vorstand
- gemeinnütziges unternehmen
- Gemeinschaftskultur
- gemini
- gemini 2.0-technologie
- gemini 2.5
- gemini 2.5 pro
- Gemini 3 Pro
- Gemini AI
- Gemini Code Assist
- gemini flash 2.0
- Gemini KI
- gemini nano xxs
- gemini robotik
- gemini ultra modell
- gemini-modelle
- gemini-pause
- gemini-plattform
- gemma
- Gemma AI
- gen-3
- gen-editing
- genai
- genai-ära
- genai-Ökosystem:
- GenAI-Videos
- genaktivität
- Genauigkeit
- genauigkeit 96
- genauigkeit in ki
- genauigkeit von chatgpt
- genbearbeitung
- gencast
- gencast-modell
- generalisierungsfähigkeit
- generation
- generative
- generative adversarial networks
- generative bearbeitung
- Generative KI
- generative ki-anwendungen
- generative ki-funktionen
- generative ki-modelle
- generative ki-strategie
- generative ki-technologie
- generative ki-tools
- generative ki-werkzeuge
- generative Suche
- generative technologie
- generative technologien
- generativen
- generativen KI
- generativer
- generativer KI
- generator:
- generators
- genetische analyse
- genetische daten
- genetische marker
- genetische sequenzen
- genetisches material
- geniale
- genie
- Genie 3
- GenKI-Apps
- genmoji
- genomanalysen
- genregulation
- gentherapie
- gentherapielösungen
- geodatenmodell
- geoffrey
- Geoffrey Hinton
- geologische fernerkundung
- geometrieprobleme lösen
- geometrische problemlösung
- geopolitik
- geopolitische analyse
- geopolitische auswirkungen
- geopolitische spannungen
- geopolitische überlegungen
- geospatial-intelligenz
- geospy
- geplant?
- geprägten
- gerade
- geraten
- gerechte gewinnverteilung.
- Gericht
- gerichtsakten
- gerichtsentscheidung
- gerichtsmedizin san francisco
- gerichtssaaltraining
- gerichtsurteil
- germanische
- geschäfts-tools
- geschäftsanalysen
- geschäftsanwendungen
- geschäftsausblick
- Geschäftserfolg
- geschäftserweiterung
- geschäftsgeheimnisse
- geschäftsinfrastruktur
- Geschäftskommunikation
- geschäftskonten
- geschäftsleben
- geschäftsmöglichkeit
- geschäftspräsentationen
- geschäftsprozessoptimierung
- geschäftstransformation
- geschäftswelt
- geschäftswert
- geschichte,
- geschichten:
- geschick
- geschicklichkeitsspiel
- geschlecht
- geschlechtsspezifische
- geschlossen
- gesehen
- gesellschaft.
- gesellschaftliche akzeptanz von robotern
- gesellschaftliche Auswirkungen
- gesellschaftliche auswirkungen der ki
- gesellschaftliche auswirkungen von ki
- gesellschaftliche konsequenzen
- gesellschaftlicher Wandel
- gesellschaftswandel
- gesetz
- gesetz über digitale dienste
- gesetzes
- gesetzesentwurf
- gesichtsanalyse
- gesichtserkennung
- gesichtserkennung fehler
- gesichtserkennungssoftware
- gesichtserkennungssystem
- gesichtserkennungstechnologie:
- gespräche
- gesprächsfluss
- Gesprächshistorie
- gesprächskontinuität
- gestalten
- gestensteuerung
- gesundheit
- gesundheits-
- gesundheitsdatenanalyse
- gesundheitsdiagnostik
- gesundheitsfragen
- gesundheitsfürsorge
- gesundheitsgerechtigkeit
- gesundheitsgewohnheiten tracking
- gesundheitskostenreduktion
- gesundheitskrisen
- gesundheitspolitik
- gesundheitssektor
- gesundheitssysteme
- gesundheitstechnik
- gesundheitstechnologie
- gesundheitstipps
- gesundheitsvorhersagen
- gesundheitswesen
- gesundheitswesen ki-anwendung
- gesundheitswesen ki-tools
- gesundheitswesens
- getty images
- gewerkschaftsreaktionen
- Gewerkschaftswarnungen
- gewicht
- Gewichtsabnahme
- gewichtsziele
- gewichtungen
- gewinnorientierter übergang
- gewinnorientierung
- gewinnt
- ghibli-stil
- ghostgpt
- gig economy
- giga
- gitarrentabulaturen
- github
- GitHub Copilot
- glashaus
- glass
- glasses
- glauben:
- gleichberechtigung
- glioblastoms
- global
- Global Summit on AI Safety
- global technology summit 2025
- global workspace theory
- globale
- globale adoptionsraten
- globale beratung
- globale einführung
- globale expansion
- globale inhalte
- globale investitionen
- globale ki-entwicklung
- globale ki-führerschaft
- globale ki-governance
- globale ki-herausforderung
- globale ki-kooperation
- globale ki-unternehmen
- globale ki-wettbewerb
- globale ki-zugänglichkeit
- globale kommunikation
- globale kundenzufriedenheit
- globale lagerverwaltung
- globale regulierung
- globale teamarbeit
- globale tech-arena
- globale tech-dominanz
- globale technologieführerschaft
- globale Umfrage
- globale wettbewerber
- globale wettbewerbsfähigkeit
- globale wetteranalyse
- globale zugänglichkeit
- globale zusammenarbeit
- globalen
- globaler einsatz
- globaler Zugang
- glowtrack-technologie
- glücksspielindustrie:
- glukosetoleranz
- gmail-ki-upgrade
- gnome
- gnomes
- god
- God Mode
- gofai
- Golf
- Golfclub
- Golfplatz Management
- google agentspace
- google ai studio
- Google Analytics
- google assistant
- google canvas
- google chirp 3
- google chrome
- google classroom
- google cloud
- google cloud ai
- google cloud credits
- google cloud next 2025
- Google DeepMind
- google docs integration
- Google Dominanz
- google flow
- google fotos vorfall
- Google Gemini
- google gemini 2.0
- google gemini 2.0 pro
- google gemini 2.5
- google gemini 2.5 pro
- google gemini cli
- google gemma 3n
- google i/o
- google i/o 2025
- Google Jules
- google ki
- google ki-strategie
- google labs
- google lens
- google maps
- google offerwall
- google one ai premium
- google pixel
- google project mariner
- google regulierung
- google search integration
- google translate
- google trends
- google unter kartellrechtlicher prüfung
- Google VaultGemma
- Google VEO
- google veo 3
- Google Vids
- google-bericht
- google-integration
- google-ki-ethik
- google-konten
- google-technologie
- googles
- Googles Coding-Assistent
- Googles Flash
- googles ki
- Googles Willow
- gorilla-erkennung
- governance
- governance-mechanismen
- govtech-markt
- gpqa diamond bewertung
- gpqa-test
- gpt
- GPT 5.1
- gpt store
- gpt-2030
- GPT-3
- gpt-3 stilllegung
- gpt-3 training
- gpt-3.5
- gpt-4
- GPT-4 Developer Livestream
- gpt-4 turbo
- gpt-4-leistung
- gpt-4-nachfolger
- gpt-4.1
- GPT-4.5
- gpt-4.5 übertrumpfung
- gpt-4.5-upgrade
- gpt-4o
- gpt-4o-mini-tts
- gpt-4o-transcribe
- GPT-5
- GPT-5.1
- gpt-generierte texte
- gpt-image-1
- GPT-J-Algorithmus
- gpt-next
- GPT-Realtime
- gpt-technologie
- gpt4all-j
- GPT5
- gptbot
- gpu-a100
- gpu-architektur
- gpu-beschleunigung
- gpu-cluster
- gpu-entwicklung
- gpu-kühltechnologie
- gpu-parallelverarbeitung
- gpu-plattform
- gpu-rechenmaschine
- grafikdesign
- grafiken:
- grafikprozessoren
- grafische benutzeroberfläche
- grafische benutzeroberflächen
- Grammarly
- Grammatik
- grammatikfehler
- granite
- graustufen
- grauzone:
- graybook.ai:
- grenzen
- grenzen der berechnung
- grenzenlose
- grenzenlosen
- Grippevorhersage
- grok
- Grok 3
- grok 3 übertrumpfung
- Grok 4 Fast
- grok-1-modells
- grok-algorithmus
- grok-assistent
- grok-modell
- Grok-Modelle
- Grokipedia
- groks
- groq
- Groq AI
- groqcloud
- großbritannien
- großbritanniens
- größe
- große sprachmodelle
- großen
- group
- grund,
- grundlage
- Grundlagenmodell
- grundlagenmodellen
- grundlegende
- gründung
- Gruppenchat
- Gruppendenken
- gsa-chat
- gsm8k
- gtc 2025
- gui-automatisierung
- gui-interaktion
- haben?
- Hacker
- hackertrick
- haften
- hajime
- hal 9000
- halbleiter
- halbleiter-beschränkungen
- halbleiter-innovation
- halbleiter-lieferketten
- halbleiterhandel
- halbleiterindustrie
- halbleitermarkt
- Halbleiterproduktion
- halluzinationen
- handdetaillierung
- Hände
- handeln
- handelsbarrieren
- Handelsbeschränkungen
- handelseinblicke
- handgeschriebenem
- handgezeichnete elemente
- handle
- handlungsorientierung
- handschrifterkennung
- hanyang universität
- hardware-beschränkungen
- hardware-fortschritte
- hardware-integration
- hardware-kompatibel
- hardware-kompatibilität
- hardware-limitierungen
- hardware-minimierung
- hardware-partnerschaft
- hardware-startup
- hardware-upgrade
- hardwareanforderungen
- hardwarebasierter schutz
- harmonie
- harmonyze
- harpy-system
- hausautomatisierung
- haushaltsgegenstände
- Haushaltshilfe
- haushaltskürzungen
- haushaltsroboter
- haushaltsrobotik
- hausreinigung
- Haussicherheit
- haustiere
- hautsensibilität
- hayao miyazaki
- hdmi-signalrisiken
- headset
- health-app überarbeitung
- heben
- heftige
- heimsicherheitssysteme
- helix
- heraus
- herausfordert
- herausforderung?
- herausforderungen
- herausforderungen bei der ki-implementierung
- herausforderungen der ki
- herausforderungen für entwickler
- Herausforderungen im Unterricht
- herausforderungen in der ki-entwicklung
- Herr der Ringe
- herstellen
- herzfrequenzüberwachung
- herzgesundheitsinnovation
- herzinsuffizienz-überwachung
- Herzkrankheiten
- heute!
- hexagon-packungsproblem
- HeyGen
- heygen:
- hidden markov models
- higgsfield ai
- high-end
- high-end-anzeigesystem
- high-end-fotografie
- high-stakes-technik
- high-tech-arbeitsplätze
- highlights
- hilfe
- himmel:
- hinaus
- hinduismus
- hinter
- hintergrundentfernung
- hintertreffen
- Hinton
- hipaa-konformität
- Historiker
- historische genauigkeit
- historischer kontext
- History
- hochauflösende bilder
- hochauflösende bildverarbeitung
- hochauflösung
- hochbandbreiten-verbindungen
- hochdurchsatz-screening
- hochgeschwindigkeitsscannen
- hochleistung
- hochmoderne
- hochrisiko-ki-anwendungen
- hochschulbildung
- hochspannung
- hochwertige bilder
- hochwertiges
- hoffnung
- hohe genauigkeitsrate
- hohe kosten
- hohe sicherheit
- höhere
- hollywood vs. ki
- Hollywood-Darsteller
- hollywood-streiks
- hollywood-streiks 2023
- Hollywood-Tech
- hollywood-unterstützung
- hollywoods ki-darstellung
- Holocaust
- holocaust-opferzahlen
- holodeck
- homogenisierung der literatur
- homoikonizität
- homomorphe verschlüsselung
- Hörbuchsprecher
- hörerlebnis:
- horizon europe
- horizontale skalierbarkeit
- html
- html-code-vorschau
- huawei
- huawei cloud
- huawei-verbot
- huftiere studie
- hugging
- hugging face
- hugging face reachy mini
- hugging face spaces
- hugging face transformers
- humanes ai pin
- humanistische KI
- humanitäre technologie
- humanoide
- humanoide roboter
- humanoider
- humanoider Roboter
- Humor
- humoranalyse
- Hundetrainer
- hunyuan turbo s
- hybrid
- Hybrid Reasoning
- hybrid-systeme
- hybridansatz im kundenservice
- hybrider ansatz
- hybrides argumentationsmodell
- hybridmodell in der medizinischen diagnose
- hype
- hyperparameter-optimierung
- hyperparameter-tuning
- hyperrealistische meisterwerke
- hyperscaler
- hyperspektrale bildgebung
- hypothalamus
- hypothesengenerierung
- Hyundai
- i2v-14b-720p
- ibm
- ibm partnerschaft
- ibm technologie
- ibm watson language translator
- ibm z17
- ibms
- ich
- iclr workshop
- ICPC
- id-verifizierung
- ide-integration
- ideen
- identitäten
- ideogram 3.0
- iflytek
- ikigai
- ikonische
- ikonischer kunststil
- illustration
- illustratoren
- Ilya Sutskever
- image
- Image Creator
- imagen
- images
- imitieren
- immersive erlebnisse
- Immobilienmakler
- immunfunktionen
- Immuntherapie
- imperial college london
- impfstoffentwicklung
- Implantat
- implementiert
- implementierung
- implementierung medizinischer ki
- implementierungsherausforderungen
- implementierungsherausforderungen in der medizin
- implikationen
- improvisierende ki
- indiana-jones-ansatz
- indien
- Indische Kultur
- induktives denken
- industrie
- industriegetriebene innovationen
- industrielle automation
- industrielle materialien
- industrielle Revolution
- industriepartnerschaften
- industrieroboter
- industriestandard
- industrietransformation
- infactory:
- inference
- inferenz-chip
- inferenz-engines
- inferenz-framework
- inferenzframework
- inferenzgeschwindigkeit
- inferenzkosten
- inferenzkosten-reduzierung
- inflection-2
- inflection:
- influencer-marketing
- Influencerin
- informatikausbildung
- informatikgeschichte
- informationen
- informationsbeschaffung
- informationsfilterung
- informationsgestaltung
- informationskriegsführung
- informationsmanipulation
- informationsverarbeitung
- informationszugang
- informierte entscheidungen
- infotainment-systeme
- infrarotsensoren
- infrastruktur
- Infrastruktur Herausforderungen
- infrastrukturkosten
- infrastrukturskalierung
- ingelheim
- Ingenieur
- Ingenieurspreis
- ingenieurstrategien
- inhalt
- Inhalte
- inhalten:
- inhaltsähnlichkeit
- inhaltsanalyse
- Inhaltserstellung
- inhaltserzeugung
- inhaltsintegrität
- inhaltskontrolle
- inhaltsmoderation
- inhaltsqualität
- inhaltsrichtlinien
- inhaltsverbesserung
- Inhaltswarnungen
- initiative,
- initiativen
- inklusive entwicklungsteams
- inklusive kriterien
- inklusivität
- innenarchitekt/in
- innenarchitektur:
- inner-guidance-mechanismus
- innovation
- innovation in der softwarearchitektur
- innovation in der softwareentwicklung
- innovation in ki
- innovation in suchtechnologien
- innovation und verantwortlichkeit
- innovationen
- innovationen in der computertechnik
- innovationsförderung
- innovationsführer
- Innovationsrevolution
- innovationsstrategien
- innovativ
- innovative
- innovative anwendungen
- innovative künstlerische ansätze
- innovative matching-ansätze
- innovative mobile lösungen
- innovative sicherheitslösungen
- innovative technologie
- innovative technologien
- innovative testmethode
- innovativen
- innovativer
- innovatives
- inpainting und outpainting
- input-manipulation
- insider-prompts
- instagram-daten
- instagram-monetarisierung
- instagram-strategien
- installieren
- Instantkauf
- integration
- integration etablierter tools
- integration in google suche
- integration in ki-anwendungen
- integration von ki-modellen
- integrationen
- integrierte ethische filter
- integrierte informationstheorie
- integrität
- integrität des justizsystems
- intel
- intelligent
- intelligente
- intelligente audiooptimierung
- intelligente automatisierung
- intelligente benachrichtigungen
- intelligente brillen
- intelligente fotografie
- intelligente gerätesteuerung
- intelligente interaktion
- intelligente kollaborationstools
- intelligente Systeme
- intelligenten
- intelligenter
- intelligenter Erfolg
- intelligenz
- intelligenzschranke
- interaktion mit ki
- interaktionen mit ki
- interaktive displays
- interaktive gesprächsschnittstellen
- interaktive lernumgebungen
- interaktive musiksteuerung
- interaktive suchergebnisse
- interaktive technologie
- interaktive werbeerlebnisse
- interaktive werbekampagnen
- interaktiver arbeitsbereich
- interaktives geschichtenerzählen
- interartliche kommunikation
- interdisziplinäre anwendungen
- interdisziplinäre forschung
- interdisziplinäres lernen
- interessenkonflikte
- interface-manipulation
- internationale geschäftskommunikation
- internationale ki-normen
- internationale ki-vereinbarung
- internationale ki-zusammenarbeit
- internationale kollaboration
- internationale kooperation
- internationale partnerschaften
- internationale präsenz
- internationale zusammenarbeit
- internationales ki-talent
- interner kompass
- internet
- Internet-Browsen
- internetinteraktion
- internetnutzerbasis
- Internetzugriff
- interpreter
- interspezifische kommunikation
- interview-simulatoren
- intuitive benutzeroberfläche
- intuitive physik
- intuitor
- investition
- investition in arizona
- investition in technologie
- investition saudi-arabien
- investitionen
- investitionen in digitalsicherheit
- investitionen in rechenzentren
- investitionsausgaben
- investitionsmöglichkeiten
- investitionsrunde
- investitionsverzögerungen
- investoren
- investorengruppe
- investoreninteresse
- ios
- ios 18.4
- ios 19
- ios 19 sdk
- ios 19.4
- ios 20
- iOS 26
- ios-entwicklung
- ios-update
- iot in der logistik
- ip-schutz
- ipad mini a17
- iphone
- iphone 15 pro
- iphone 16
- iPhone 17
- iPhone App
- iphone-datenanalyse
- iphone-verkäufe
- ipo-analyse
- iris-scanning
- irland
- isaac gr00t n1
- isaac plattform nvidia
- Island
- isolationsbekämpfung
- isometric
- israelische
- italien
- iterative bewertung
- iterativen
- ivf-technologie
- jahr
- jahren
- jahres
- Jahresumsatz
- jahrhundert
- Jailbreaking
- jamba:
- james
- James Sanborn
- japanische kishōtenketsu-tradition
- japans
- jarvis.ai
- jeff bezos
- jenseits
- Jensen Huang
- jetbrains ides
- jetpack
- Job ID
- job_id
- job-matching-plattformen
- jobautomatisierung
- JobID
- jobprofil:
- jobsuche
- jobsuchplattformen
- jobverlust durch automatisierung
- Jobvermittlung
- Joelle Pineau
- johansson
- john cage
- john mccarthy
- John Schulman
- joint-venture
- joke analysis and production engine
- jony ive
- jordan
- Jordan Peterson
- josé penadés
- joseph weizenbaum
- journalismus:
- jpmorgan
- Jugendliche
- Juilliard
- jules developer code agent
- junge
- junge chinesen
- jüngste
- jüngsten
- juristische
- juristische ki-anwendungen
- justiz:
- Künstlerischer Ausdruck
- kai-fu
- kalenderintegration
- kalifornien
- kalter krieg
- kamera
- kamera-basierte interaktion
- Kamerarolle-Analyse
- kameraspezifikationen
- kamerawinkel steuern
- kampagne
- kampagnen
- kampf
- kanada wasserkraft
- kann
- kanto-region
- kapitalerhöhung
- Kapitalismus
- karriere
- Karriere Schutz
- Karrierefolgen
- karriereförderung
- karriereveränderung
- karrierewandel
- kartellrecht
- kartellrechtliche prüfung
- kartellrechtsklagen
- Katze
- kausale frameworks
- keine softwareinstallation
- kennzeichnung
- kernfusion
- key-wort
- keywords
- KI
- KI 2024
- KI am Arbeitsplatz
- KI Animation
- KI Anwendungen
- KI Aufpasser
- KI Auswirkungen
- KI Automatisierung
- KI Begleiter
- KI Betrug
- KI Bewusstsein
- KI Bildbearbeitung
- KI Bildung
- KI Blogging
- KI Chemie
- KI Chips
- KI Copywriter
- KI Copywriting
- KI Datenschutz
- KI Design
- KI Dienste
- KI Dummheit
- KI Einfluss
- KI Emotionen
- KI Entscheidungen
- KI Erfolg
- KI Erkennung
- KI Fähigkeiten
- KI Fehler
- KI Forschung
- KI Fotobearbeitung
- KI Fragen
- ki für unternehmen
- KI Gedächtnis
- KI Halluzination
- KI Ideen
- ki im bildungsbereich
- ki im bildungswesen
- ki im design
- ki im einzelhandel
- ki im filmproduktionsprozess
- ki im gesundheitswesen
- KI im Marketing
- KI im Weltraum
- KI in 2023
- ki in bildung
- ki in den 1980er jahren
- ki in der bildung
- ki in der energie- und abfallwirtschaft
- ki in der filmproduktion
- ki in der gesundheitsversorgung
- ki in der humanitären hilfe
- ki in der kriegsführung
- ki in der literatur
- ki in der mathematik
- ki in der medizin
- ki in der mineralexploration
- ki in der mode
- ki in der politik
- ki in der rechtswissenschaft
- ki in der schönheitsindustrie
- ki in der tierforschung
- ki in der verteidigung
- ki in finanzberatung
- ki in finanzinstituten
- ki in kreativen industrien
- ki in online-interaktionen
- ki in programmierung
- KI Inhalte
- KI Jobs
- KI Journalismus
- KI Kapazität
- KI Kommunikation
- Ki Konkurrenten
- KI Kostenreduktion
- KI Kunst
- KI Lernen
- KI Musik
- KI Planung
- KI Potential
- KI Prompts
- KI Regulierung
- KI Richtlinien
- KI Satelliten
- KI Sprache
- Ki Sprachmodelle
- KI Suche
- KI System
- KI Technologie
- Ki Texte
- KI Tools
- KI Training
- ki und arbeitsmarkt
- ki und arbeitszufriedenheit
- ki und erpressung
- ki und ethik
- ki und internationales recht
- ki und kindersicherheit
- ki und literatur
- ki und menschenrechte
- ki und menschliche evolution
- ki und neutralität
- ki und verschwörungstheorien
- KI Unternehmen
- KI verbieten
- KI verstehen
- KI Vorteile
- KI Waffe
- KI Wasserzeichen
- KI Wettervorhersage
- KI Zukunft
- KI технологий
- KI-Abkommen
- ki-abschaltverhalten
- ki-adoptionsraten
- ki-agent
- KI-Agenten
- ki-aktien
- ki-akzentmodifikation
- ki-akzeptanz
- ki-algorithmen
- ki-analyse
- KI-Angriff
- KI-Ängste
- ki-animationssteuerung
- ki-anwendung
- ki-anwendungen
- ki-Ära
- ki-arbeitskräfteentwicklung
- KI-Arbeitsplatz
- ki-architekt
- ki-assistent
- ki-assistent operator
- ki-assistent wettlauf
- ki-assistenten
- ki-assistenten in der entwicklung
- ki-assistentenkombination
- KI-Audio
- ki-audio-fortschritt
- ki-aufsicht
- ki-augen
- KI-Ausbeutung
- ki-ausbildung
- ki-autonomie
- ki-avatare
- ki-basierte interaktionen
- ki-basierter
- KI-Bearbeitung
- ki-beauftragte
- KI-Bedrohung
- ki-begleiter
- ki-begleiter in zoom
- ki-benchmark-tests
- ki-benchmarking
- ki-benchmarks
- ki-beratung
- ki-beratungsunternehmen
- ki-bereitschaftsbewertung
- KI-Bereitstellung
- ki-beschleuniger
- ki-beschleunigte wissenschaft
- ki-beschleunigung
- ki-betriebssystem
- ki-betrugserkennung
- ki-bewertungssystem
- ki-bewusstsein
- ki-bewusstseins-debatte
- ki-bewusstseinsforschung
- ki-bewusstseinstest
- ki-bildeditors
- ki-bilder
- ki-bildern
- ki-bilderstellung
- KI-Bilderzeugung
- ki-bildgenerator
- ki-bildgenerierung
- ki-bildmanipulation
- KI-Bildmodell
- ki-bildung
- ki-bildungstechnologie
- ki-bot ernie
- ki-bot-blockade
- ki-bots
- KI-Branche
- KI-Brille
- ki-browser
- ki-bug-bounty-programm
- ki-business-programm
- ki-charaktere
- ki-chatbot
- ki-chatbots
- ki-chatgpt
- ki-chemie-simulationen
- KI-Chip
- ki-chip-strategie:
- ki-chips
- ki-codierungsassistenten
- ki-codierungsfunktionen
- ki-coding
- ki-coding-agent
- ki-coding-agenten
- ki-coding-assistenten
- ki-coding-tools
- ki-community
- ki-compliance
- ki-computing
- KI-Content
- ki-content-erstellung
- ki-crawler
- ki-datenrechte
- KI-Dating
- ki-debugging
- ki-deepfake-themas
- ki-denkprozesse
- ki-denkwerkzeug
- ki-designhilfe
- ki-desktop-roboter
- ki-dienstleistungen
- ki-diffusionsregel
- ki-dj
- ki-dj-funktion
- ki-dokumentenverarbeitung
- KI-Dominanz
- ki-durchbruch:
- ki-durchbrüche!
- ki-dynamik
- ki-e-mail-management-tools
- ki-effekte
- KI-Effizienz
- ki-effizienzgewinne
- ki-ehrlichkeit
- ki-einfluss auf kreativität
- ki-einfluss auf medien
- ki-einkaufsassistent
- ki-einnahmequellen
- ki-einsatz in unternehmen
- ki-empfehlungen
- ki-energiekrise
- ki-energieverbrauch
- ki-energieversorgung
- ki-entscheidungsfindung
- ki-entscheidungsprozesse
- ki-entwicklerkonferenz
- ki-entwicklung
- ki-entwicklung und arbeitsplatzbedarf
- ki-entwicklungen
- ki-entwicklungspraktiken
- ki-entwicklungswerkzeuge
- KI-Erkennung
- ki-erweiterungen
- ki-erzählern:
- KI-Ethik
- ki-ethiker
- ki-ethikskandal
- KI-Ethische Fragen
- ki-ethische standards
- ki-evolution:
- ki-experte
- ki-expertise
- ki-exzellenzzentrum
- KI-Fabrik
- ki-fähigkeit,
- ki-fähigkeiten
- ki-fähigkeitserweiterung
- ki-fairness
- ki-faktenprüfung
- ki-fehler
- ki-fehler im rechtswesen
- ki-fehlinformation
- ki-fehlkommunikation
- ki-fehlverhalten
- ki-filmemachen
- ki-finanzierung
- ki-firmen
- KI-Firmenstadt
- ki-flirtspiel
- ki-flüchtlingsavatare
- ki-forscher
- ki-forschung
- ki-forschung und -entwicklung
- ki-forschungsförderung
- ki-forschungswachstum
- ki-fortschritt
- ki-fortschritte
- ki-fortschritten
- KI-Fotobearbeitung
- ki-fotofunktionen
- ki-framework
- ki-frameworks
- ki-fruchtbarkeitsbehandlung
- KI-Führungskräfte
- ki-führungsposition
- ki-funktionalitäten
- ki-funktionen
- ki-gaming
- ki-gemeinschaft
- ki-genauigkeit
- ki-generator
- ki-generierte
- ki-generierte animation
- ki-generierte assets
- ki-generierte inhalte
- ki-generierte musik
- ki-generierte videos
- ki-generierte zusammenfassungen
- ki-generierten
- ki-generierter
- KI-Generierung
- KI-Gesetz
- ki-gesetzgebung
- ki-gesichtserkennung
- ki-gesprächsfähigkeiten
- KI-gesteuert
- ki-gesteuerte
- ki-gesteuerte analysen
- ki-gesteuerte bedrohungserkennung
- ki-gesteuerte bildunterschriften
- ki-gesteuerte brillen
- ki-gesteuerte code-generierung
- ki-gesteuerte dialoge
- ki-gesteuerte entscheidungsfindung
- ki-gesteuerte entwicklungstools
- ki-gesteuerte gespräche
- ki-gesteuerte investitionsstrategien
- ki-gesteuerte kommunikation
- ki-gesteuerte logistik
- ki-gesteuerte maschinen
- ki-gesteuerte partnersuche
- ki-gesteuerte plattform
- ki-gesteuerte produkte
- ki-gesteuerte sicherheitslösungen
- ki-gesteuerte suche
- ki-gesteuerte verteidigungswerkzeuge
- ki-gesteuerte videokonferenzen
- ki-gesteuerte visuelle effekte
- ki-gesteuerte werbung
- ki-gesteuerte werkzeuge
- ki-gesteuerte wirtschaft
- ki-gesteuertem
- ki-gesteuerten
- ki-gesteuerter
- ki-gesteuerter fußscanner
- ki-gesteuerter mainframe
- ki-gesteuertes
- ki-gesteuertes internet
- ki-gestützte
- ki-gestützte analyse
- ki-gestützte artikelerstellung
- ki-gestützte arzneimittelentwicklung
- ki-gestützte autos
- ki-gestützte bildbearbeitung
- ki-gestützte chatbots
- ki-gestützte code-reviews
- ki-gestützte datenbanken
- ki-gestützte design-plattform
- ki-gestützte dienste
- ki-gestützte genomik
- ki-gestützte geschäftsentwicklung
- ki-gestützte gesundheitsversorgung
- ki-gestützte inhaltserstellung
- KI-gestützte Lösungen
- ki-gestützte materialwissenschaft
- ki-gestützte plattform
- ki-gestützte produktentwicklung
- ki-gestützte produktivität
- ki-gestützte programmierhilfe
- ki-gestützte proteinsynthese
- ki-gestützte robotik
- ki-gestützte suche
- ki-gestützte unterrichtsplanung
- ki-gestützte verbesserungen
- ki-gestützte website-erstellung
- ki-gestützte werbesperrung
- ki-gestützte werbung
- ki-gestützte werkzeuge
- ki-gestützten
- ki-gestützter browser
- ki-gestütztes
- ki-gestütztes programmieren
- ki-gestütztes storytelling
- ki-gesundheitsrevolution
- KI-Gigant
- ki-giganten
- KI-Gipfel
- ki-gipfel paris
- ki-governance
- ki-grafik-
- ki-grenzen
- ki-halluzinationen
- ki-handelsroboter
- ki-hardware
- ki-helfer-technologien
- ki-helm
- KI-Herausforderung
- ki-herausforderungen
- ki-highlights
- KI-Hilfe
- ki-humor
- ki-hybrid-reasoning
- ki-identitätswechseln
- ki-im-kino
- ki-implementierung
- ki-implementierungsphilosophie
- ki-industrie
- ki-inferenzfähigkeiten
- KI-Influencer
- ki-influencern
- ki-infrastruktur
- ki-infrastrukturentwicklung
- ki-infrastrukturinvestitionen
- ki-ingenieure
- ki-inhalten
- KI-Inhaltserstellung
- ki-inhaltskennzeichnung
- ki-inhaltsmoderation
- ki-initiative
- ki-initiativen
- KI-Innovation
- ki-innovation naher osten
- ki-innovationen
- ki-innovationsplattform
- ki-inspirierte
- ki-integration
- ki-integration am arbeitsplatz
- ki-integrierter browser
- ki-interaktion
- ki-interaktionen.
- ki-investition
- ki-investitionen
- ki-jahr
- ki-kapazitätsanforderungen
- ki-kenntnisse
- ki-klassifizierungssystem
- ki-klonwerkzeuge
- ki-kommerzialisierung
- ki-kommunikation:
- ki-kommunikationsstil
- ki-kompetenz
- KI-Konkurrenz
- ki-konsolidierung
- ki-kontrolle
- ki-kontroverse
- ki-kontroversen
- ki-konversation
- KI-Kooperation
- ki-kosten
- ki-kostenanalyse
- ki-kraftwerk china
- KI-Krieg
- ki-kriegsführung
- ki-kritik
- ki-krücke
- ki-kulturkrieg:
- ki-kundensupport
- ki-kunst-prompts
- ki-kunstgeneratoren
- ki-kunstgenerierung
- ki-künstler
- ki-künstlern
- ki-kunstproduktion
- ki-kunstwerken
- ki-kurs
- KI-Labor
- ki-labyrinth
- ki-lebenslaufschreiben
- ki-leistung
- ki-leistungsbewertung
- ki-linienrichter
- ki-logik
- ki-lösung
- ki-lösungen
- ki-lügendetektion
- ki-magie
- ki-malvorlagen
- ki-manipulation
- ki-manipulationen
- ki-marketing
- KI-Markt
- ki-markt china
- ki-marktanteil
- ki-markteinfluss
- ki-markteinführung
- ki-marktplatz
- ki-matching
- ki-maussteuerung
- ki-medizintechnik
- ki-mensch-kommunikation
- ki-mensch-partnerschaft
- ki-metaphern
- ki-mikrochips
- ki-militäranwendungen
- KI-Minister
- KI-Missbrauch
- ki-missbrauch verhindern
- KI-Misserfolge
- ki-mitarbeiterbindung
- ki-modell
- ki-modell gemini 2.0
- ki-modell qwen
- ki-modell-ausgaben
- ki-modell-inferenz
- ki-modell-neueinführung
- ki-modelle
- ki-modelle 2024/2025
- ki-modelle teilen
- ki-modellen
- ki-modellfamilie
- ki-modellierung
- ki-modellleistung
- ki-modells
- ki-modellzulassungen
- ki-moderation
- ki-moderationslösungen
- ki-modernisierung
- KI-Modus
- ki-monitoring deutschland
- ki-musik
- ki-musikgenerierung
- ki-musikproduktion
- ki-musikregulierung
- ki-musikvideos
- ki-nachrichten
- ki-nacktbilder
- ki-native schnittstellen
- ki-nativen ide
- ki-neuigkeiten
- ki-neuverfilmungen
- ki-news
- KI-Notenvorhersage
- ki-nutzererlebnis
- ki-nutzung
- ki-nutzungsrichtlinien
- ki-nutzungsverbot
- ki-ökosystem
- ki-ökosysteme
- ki-optimierung
- ki-optimierungs-durchbruch
- ki-outfit-anpassung
- ki-paradigmen
- KI-Partnerschaft
- ki-partnerschaften
- ki-personalisierung
- ki-pionier
- ki-plattform
- ki-plattformen
- ki-podcast-generator
- KI-Podcasts
- ki-politik
- ki-portraitgenerierung
- ki-potenzial
- ki-potenzials
- ki-power-user
- ki-preiskrieg
- KI-Problemlösung
- ki-produktentwicklung
- ki-produktivität
- ki-programm
- ki-programmier-revolution
- ki-programmiermodelle
- KI-Programmierung
- ki-programmierwerkzeug
- ki-projekt
- ki-projektmanagement
- KI-Prompter
- ki-promptgeneratoren
- KI-Prompts
- KI-Psychose
- ki-puls:
- ki-rahmenwerke
- ki-ranglisten
- ki-rankings
- ki-reaktion
- ki-reasoning
- ki-reasoning-fähigkeiten
- ki-reasoning-modelle
- KI-Rechenschaftspflicht
- ki-rechenzentren
- ki-rechenzentrum abu dhabi
- ki-regeln:
- ki-regulation
- KI-Regulierun
- KI-Regulierung
- ki-regulierungen
- ki-rekrutierung
- KI-Rennen
- ki-rennen:
- KI-Revolution
- ki-revolution:
- ki-risiken
- ki-risikomanagement
- ki-risikoniveaus
- ki-roboter
- ki-roboter-fußball
- ki-roboterarm
- ki-robotik
- ki-rollenspiele
- KI-Schauspielerin
- ki-schlussfolgern
- KI-Schrecken
- ki-schreibassistent
- ki-schreiben
- ki-schreibwerkzeug
- KI-Schreibwerkzeuge
- ki-schulung
- ki-schulung für lehrer
- ki-schulungen
- ki-schutzmaßnahmen
- ki-scraper
- ki-scraping
- ki-screening-systeme
- KI-Seitenleiste
- ki-sektor
- ki-sektor konsolidierung
- ki-selbsterhaltung
- KI-Server
- KI-Shopping
- ki-shopping-tool
- Ki-Sicherheit
- ki-sicherheits-workshop
- ki-sicherheitsbedenken
- ki-sicherheitsberichte
- ki-sicherheitsforschung
- ki-sicherheitsmythos
- ki-sicherheitsprotokolle
- ki-sicherheitsrat
- ki-sicherheitsstandards
- ki-side-hustles
- ki-simulation
- ki-simulationen
- KI-Siri
- ki-slop:
- ki-smart-brille
- ki-softwareentwicklung
- ki-souveränität
- ki-speicherfunktionen
- ki-spiele
- ki-spiele-engine
- ki-spieleentwicklung
- ki-spielzeug
- ki-sprachassistent
- KI-Sprache
- ki-spracherkennung
- KI-Sprachmodell
- ki-sprachtechnologie
- KI-Startup
- ki-startup-förderprogramm
- ki-startup-studio
- ki-startup-wachstum
- ki-startup,
- ki-startups
- KI-Stethoskop
- KI-Stimme
- ki-stimmen
- KI-Stimmengenerator
- ki-stimmklonung
- ki-stimmmodellierung
- ki-stimmmodulation
- ki-strategen
- ki-strategie
- ki-strategien
- KI-Stresstests
- ki-subventionssystems
- KI-Suche
- ki-suchtechnologie
- ki-super-assistent
- ki-supercluster
- ki-supercomputer
- ki-supertest
- ki-suprematie
- ki-system
- ki-system fehler
- ki-systeme
- ki-systemen
- ki-szenenoptimierung
- ki-talente
- ki-talentkampf
- ki-täuschung
- ki-tech-riese
- ki-technik
- ki-technologie
- KI-Technologien
- ki-telefon
- KI-Tests
- ki-text-zu-musik-generator
- KI-Therapie
- ki-therapie-chatbots
- KI-Tool
- KI-Tools
- ki-tools für kreative
- ki-tools für programmierer
- ki-tools für unternehmen
- ki-tools für verwaltungsaufgaben
- ki-tools in der bildung
- KI-Training
- ki-training durch journalisten
- ki-trainingsdaten
- ki-trainingsdatensätze
- ki-trainingsproblemen
- KI-Transformation
- ki-transkriptionsfehler
- ki-transparenz
- KI-Trend
- ki-trends:
- ki-tutor
- ki-twist
- ki-überarbeitung
- ki-überblicke
- ki-überholung
- ki-übersetzungs-apis
- ki-übersetzungskopfhörer
- ki-Übersichten:
- ki-überwachung
- KI-Umsatz
- ki-ungleichheit
- ki-unternehmen
- ki-unterstützte forschung
- ki-unterstützte tools
- ki-unterstütztem
- KI-Unterstützung
- ki-unterstützung für allgemeinmediziner
- ki-untertitelübersetzung
- ki-update:
- ki-updates
- ki-upgrade
- ki-urheberrechten
- ki-urheberrechtsausnahme
- ki-urheberrechtsstreit
- ki-validierung
- ki-verantwortlichkeit
- ki-verbesserte fotografie
- ki-verbesserungen
- ki-verdrängung
- ki-vereinfachung
- KI-Verhaltenskodex
- ki-verhaltensmuster
- ki-verifikation
- ki-verkäufer
- KI-Verordnung
- ki-versagen
- ki-verstöße
- ki-vertragsverhandlungen
- ki-verzögerungen
- ki-video
- ki-video-modell
- ki-video-tools
- ki-videoaktualisierungen
- ki-videobearbeitung
- ki-videogeneration
- ki-videogenerator
- ki-videogenerierung
- ki-videomodelle
- ki-videoproduktion
- KI-Videos
- ki-visuelle durchbrüche
- ki-voreingenommenheit
- KI-Vorherrschaft
- KI-Vorhersagen
- ki-vorschriften
- ki-vorstoß
- ki-wachstum
- ki-webintegration
- ki-welt
- KI-Welten
- ki-weltraum-computing
- ki-werbung
- ki-werkzeuge
- ki-wettbewerb
- ki-wettbewerbsnachteil
- KI-Wette
- ki-wettrüsten
- ki-winter
- ki-wirtschaftswachstum
- ki-wissenschaftler
- ki-wohlbefinden
- ki-workflows optimieren
- ki-wurm-bedrohung
- ki-zar:
- ki-zeichentrickfilme
- ki-zensur
- ki-zertifizierungen
- ki-zielausrichtung
- ki-zuerst-strategie
- ki-zufallsmodellen
- ki-zugänglichkeit
- KI-Zukunft
- ki-zukunftsfonds
- KI-Zusammenfassung
- ki-zuverlässigkeit
- ki-zwischenfall:
- killerrobotern:
- kinder
- Kinderarbeit
- kinderbüchern
- Kindergartenansatz
- kindersicherheit
- Kindersicherung
- kiss:
- kitzel
- kl730
- Klage
- klang
- klaren
- klarheit
- klarna
- klartextpasswörter
- Klassenzimmer
- klassifizierte materialien
- klavierfähigkeiten
- kleine Betriebe
- kleine teams
- kleine unternehmen
- klimawandel
- klimawissenschaft
- klimaziele und ki
- klinische studien
- klinische validierung
- klinisches wissen
- klonen
- kluft
- kneron
- knowledge engineering
- knowledge graph
- koalitionspolitik
- kobie
- kognitive analyseplattform
- kognitive auswirkungen ki
- kognitive entwicklung
- kognitive freiheit
- kognitive Kluft
- kognitive psychologie
- kognitive schulden
- kognitive verhaltenstechniken
- kognitive wissenschaft
- kollaborationsfunktionen
- kollaborationsfunktionen im gesundheitswesen
- kollaborationstool
- kollaborative funktionen
- kollaborative ki-plattform
- kollaborative partnerschaften
- kollaborative Tools
- kollaborative umgebung
- kollaborativen
- kollaborativer
- kollisionserkennung
- kolorieren
- kombinierte vorhersagemodelle
- kommende
- Kommentator
- kommentatorin
- kommerzielle kunstplattform
- kommerzielle sicherheit
- kommerzieller erfolg
- kommerzielles wachstum
- kommunikation
- kommunikationsbarrieren
- kommunikationslücken
- kommunikationstechnologie im gesundheitswesen
- kompakt
- kompakte
- kompakte Gemma
- kompakte ki-entwicklung
- kompaktes design
- komplexe aufgaben
- komplexe problemlösungen
- komplexen
- komplexer
- komplexität
- komplexitäten
- konflikt:
- könig
- konkurrenz
- konkurrenz im browsermarkt
- konkurrenzangebote
- könnte
- konsequenzen
- konsolidierungseffekte
- konsumtreiber
- kontext-engineering
- kontextbeibehaltung
- kontextlänge
- kontexts
- kontextsensitive
- kontextuelle analyse
- kontextuelle erkennung
- kontextuelles bewusstsein
- kontextuelles verständnis
- kontinuierliche pädagogische unterstützung
- kontinuierliche überwachung
- kontinuierliche verbesserung
- kontinuierlichen
- kontinuierliches lernen
- kontrolle
- kontrolle über ki
- Kontrollverlust
- kontrollzentrum
- kontroverse
- kontroversen
- kontroverser
- konversation
- konversationale agenten
- konversationale ki
- konversationelle ki
- konversationen:
- Konversations-KI
- konversationsfähigkeit
- konversationsfähigkeiten
- konversationsintelligenz
- konzeptkunst
- kooperation
- koordinierte angriffe
- kopf:
- korbit
- körper
- korrigieren
- kosmetik
- Kosmos Plattform
- kosten von ki-modellen
- kosteneffiziente technologie
- kosteneffizientes lernen
- kosteneffizienz
- kosteneinsparungen
- kostengünstige
- kostengünstige automatisierung
- kostengünstige schreiblösungen
- kostenlos
- kostenlose
- kostenlose animationswerkzeuge
- kostenlose ki-modelle
- kostenlose ki-tools
- kostenlose testversion
- kostenlose tools
- kostenlosem
- kostenloser
- kostenloses angebot
- kostenmanagement
- kostenpflichtige version
- kostenreduktion
- kostensenkung
- kostenwirksamkeit
- kraft
- krankenakten
- krankenhausaufenthalte verhindern
- krankheitseradikation
- kreativ
- kreativbranche
- kreative
- kreative Anwendungen
- kreative arbeit
- kreative authentizität
- kreative ergebnisse
- kreative freiheit
- kreative generierung
- Kreative Grenzen
- kreative industrien
- kreative koexistenz
- kreative kontrolle
- kreative möglichkeiten
- kreative potenzial
- Kreative Projekte
- kreative qualität
- kreative technologie
- kreative Tools
- kreative Transformation
- kreative visualisierungen
- kreative Werkzeug
- kreative werkzeuge
- kreativen
- kreatives
- kreatives eigentum
- kreatives Schreiben
- kreativindustrie
- kreativität
- kreativität in videos
- kreativitätsförderung
- Krebsbehandlung
- Krebserkennung
- krebsmanagement
- Krebsmedikamente
- krebsprävention
- krebsprogression
- krebsüberlebensraten
- krebsüberlebensvorhersage
- krebsversorgung
- kreditkarteninformationen
- krieg
- kriegsführung
- Kriminalität
- krisenintervention
- kritik
- kritik an freiheitsstädten
- kritikalität von arbeitsplätzen
- kritiken
- kritische denkfähigkeiten
- kritische entscheidungen
- kritische mineralien
- kritisches denken
- kritisiert
- krypto-botnets
- krypto-crackdown
- kryptoanalytiker
- kryptographie
- Kryptos
- kryptos-skulptur
- kühne
- kultur
- kulturelle
- kulturelle akzente
- kulturelle aneignung
- kulturelle debatte
- kulturelle identität
- kulturelle innovation
- kulturelle nuancen
- kulturelle perspektiven
- kulturelles
- kundenakquise
- kundenbetreuung
- kundendatenplattformen
- kundendienstproduktivität
- kundendienstsysteme
- kundenengagement
- kundenerfahrung
- kundenerlebnis
- kundenerlebnis verbessern
- kundeninteraktion
- kundenservice
- kundenservice-automatisierung
- kundenservice-probleme
- kundenspezifische illustrationen
- Kundenspezifische Modelle
- kundenspezifischer
- kundensupport
- kundenverhaltensanalyse
- kündigt
- kunlun-chips
- kunst
- kunstdiebstahl
- kunstgeneratoren
- kunstideen
- künstler
- künstlerische authentizität
- künstlerische grenzen
- künstlerische integrität
- künstlerische kollaboration
- künstlerische kreativität
- künstlerische prinzipien
- künstlerische projekte
- künstlerischem
- künstlerischer ausdruck
- künstlerischer hoax
- künstlern
- künstlerplattform
- Künstlerrechte
- künstlervergütung
- künstliche
- künstliche allgemeine intelligenz
- Künstliche Dummheit
- künstliche Intelligenz
- Künstliche Intelligenz (KI)
- künstliche intelligenz ethik
- künstliche intelligenz im e-commerce
- künstliche intelligenz in der lieferverfolgung
- künstliche intelligenz in der musik
- künstliche intelligenz in der popkultur
- künstliche intelligenz in unternehmen
- künstliche intelligenz und kreativität
- künstliche intellizienz
- künstliche profile
- künstliche superintelligenz
- künstlichen
- künstlicher
- künstliches Bewusstsein
- künstliches Leben
- kunstmarkt
- kunstwelt
- kunstwerke
- kupferskulptur
- kurs
- Kurse
- Kursus
- kurzform
- Kybernetik
- l’oréal:
- L'Oréal
- laborautomatisierung
- Labordaten
- labs
- lagerautomatisierung
- laion
- lake
- LaMDA
- lanciert
- landsat-plattform
- landschaft
- landwirtschaft
- langer
- langform-animationen
- langfristige beziehungen
- langfristige nützlichkeit
- langkontext-optimierung
- langzeitforschung
- langzeitgedächtnis
- large language models
- Lärmschutz
- Larry Page
- laserdruck
- laserkommunikation
- lässt:
- lastwagen
- lateinamerika
- latenzreduzierung
- laufen
- läuft
- lauschangriffe
- laut
- lautäußerungen von tieren
- läutet
- lawzero
- leadgenerierung
- leak
- learning
- lebensechte
- lebenserwartung
- lebenslanges
- lebenslauf-optimierung
- lebenslaufgeneratoren
- lebensmittelverschwendung
- Lebensveränderung
- Lebenswissenschaften
- lees
- Legacy-Plattform
- legal
- legal-tech-initiative
- legendärer
- legitime interessen
- Lehrer und Technologie
- lehrerfortbildung
- lehrerin
- lehrerunterstützung durch ki
- lehrmethoden
- lehrplanentwicklung
- leise arbeitsweise
- leistung
- leistungsanalyse
- leistungsbenchmarks
- leistungsbeurteilung
- leistungsbewertung
- leistungseinbußen
- leistungsfähigkeit
- leistungsoptimierung
- leistungsstarke
- leistungsstarken
- leistungsstarkes
- leistungssteigerung
- leistungsvalidierung
- leistungsvergleich
- leitender
- leitet
- leitfaden
- lektion
- Lens Live
- lens studio
- leonardo
- leonardo.ai:
- lernalgorithmen
- lernen
- lernens
- Lernmethoden
- lernrate
- Leserbindung
- letzten
- leuchtende proteine
- level
- Lexica
- LG-Unternehmen
- licht:
- lichtbasierten
- lichtreflexionen
- lidar-technologie
- liebe-hass-beziehung
- liebt
- lieferkettenmanagement
- lieferkettenresilienz
- Lieferung
- life2vec
- lightmatter:
- linkedin-benachrichtigungen
- linksorientierte tendenzen
- linux-distribution
- liquid glass ui
- lisa
- LISP
- listen:
- literarische darstellung von ki
- live-streaming
- livestream
- lizenzänderungen
- lizenzgebühren
- lizenzmarkt
- lizenzmindestanforderung
- lizenzvereinbarungen
- LLaMA
- llama 3.1-architektur
- llama 4
- llama ai
- llama nemotron
- Llama Stack
- llama-konkurrent
- llama-modell
- llama-modelle
- llamacon-konferenz
- llm-fähigkeiten
- LLM-Reasoning
- llm-risiko
- llm-sicherheit
- llm-startup
- LLMs
- LLMs und kognitives Computing
- llms-sicherheitslücke
- LMARENA
- local
- Lochkarten
- logische rätsel
- logische schlussfolgerungen
- logisches denken
- logistikautomation
- logo-design
- Löhne
- lohnt
- lokale bereitstellung
- lokale datenverarbeitung
- lokale gesetze
- lokale KI
- lokale partnerschaften
- lokale sprachmodelle
- lokale wetterprognosen
- lokalisierte ki-funktionen
- loki:
- lora-integration
- LoRA-Training
- lösen
- löst
- lösung
- lösungen
- lotteriedaten
- low-rank-kompression
- lpus
- lücke
- lüftet
- lungenkrebserkennung
- luxusmarken
- lyria 2
- lyrics-chain-of-thought
- macbook 32 gb ram
- Machine Learning
- machine learning in der biotechnologie
- machine-learning-modelle
- machine-learning-plattform
- macht,
- machtkampf
- macos monterey
- macos-entwicklung
- mad
- mad max
- made in china 2025
- magenta ai-betriebssystem
- magischen
- magneten
- mai-1
- mainframe-technologie
- mainstream
- majorana 1 chip
- majorana-teilchen
- malware
- malware-erstellung
- mamba-modell
- mamba-technologie
- MAML
- mammographie
- management
- manipulation
- manipulation durch ki
- manipulation von chatbots
- manipulationsplanung
- manipulationsprävention
- manipulationsrisiko
- manipuliert
- manus ai
- marilyn
- marine
- marionetten
- mark cuban
- mark zuckerberg
- markengemeinschaften
- markenrecht
- markenrechtsverletzung
- markentreue
- marketing
- marketing visuals
- marketing-automation
- marketing-automatisierung
- marketing-content-erstellung
- marketingeffizienz
- marketingmaterialien
- marketings
- marketingtechnologien
- markt
- markt-konsolidierung
- marktanalyse
- marktanforderungen
- marktanteile
- marktbedingungen
- marktbeeinflussung
- marktbeherrschung google
- marktdominanz
- marktdynamik
- marktdynamiken
- märkte
- markteinführungsstrategie
- marktforschung
- marktforschungstool
- marktkapitalisierung
- marktkonkurrenz
- Marktmodellen
- marktmustererkennung
- marktposition
- marktpräsenz
- marktreaktionen
- marktsegmente
- marktstimmung
- marktstrategie
- markttransformation
- marktvolutalität
- marktwachstum dating-plattformen
- marktwert,
- marktwettbewerbsfähigkeit
- markunsicherheit
- mars
- Mars-Missionen
- Martin Frost
- Marvin Minsky
- mary meeker
- maschine
- maschinelle effizienz
- maschinelle intelligenz
- maschinelle kognition
- maschinelle präzision
- maschinelle wahrnehmung
- maschinellen
- maschinelles
- maschinelles bewusstsein
- maschinelles denken
- maschinelles Lernen
- maschinelles lernen im gesundheitswesen
- maschinelles verlernen
- maschinen
- maschinengenerierte arbeiten
- maschinengenerierte inhalte
- maschinenlernen
- maschinenlernende algorithmen
- maschinenrebellion
- maschinenübersetzung
- maßgeschneiderte gesundheitsempfehlungen
- maßgeschneiderter prozessor
- massive
- massiven
- massives
- maßstäbe
- master
- materialentwicklung:
- materialien
- Materialinnovation
- materialwissenschaft
- materialwissenschaften
- mathematik
- mathematik-olympiade
- mathematikbildung
- mathematiklösungen
- mathematische argumentation
- mathematische Beweise
- mathematische herausforderungen
- mathematische problemlösung
- mathematisches denken
- Matrix-Game
- matrix-multiplikation
- mattel
- maverick modell
- max
- maximieren
- maximierung
- mc-bench
- mcculloch-pitts-modell
- McDonald's
- mcdse-2b
- mckinsey studie
- media
- media intelligence
- medien
- medien und technologie
- medieninnovation
- medienkompetenz
- medienlandschaft
- Medikamente
- medikamentenentwicklung
- Medizin
- mediziner
- medizinische anwendungen
- medizinische automatisierung
- medizinische bildanalyse
- medizinische bildgebung
- medizinische datenanalyse
- medizinische diagnose
- medizinische diagnosetools.
- medizinische diagnostik
- medizinische durchbrüche
- medizinische ethik
- medizinische forschung
- medizinische Intelligenz
- medizinische KI
- medizinische versorgung
- medizinische zusammenarbeit
- medizinischer chatbot
- medizintechnik
- medprompt-technik
- meeressäuger
- meeting coach-tool
- meeting-effizienz
- mehrheit
- mehrparteienberechnung
- mehrsprachig
- mehrsprachige
- mehrsprachige anwendungen
- mehrsprachige aufgaben
- mehrsprachige inhalte
- mehrsprachige kommunikation
- mehrsprachige sprachgenerierung
- mehrsprachige unterstützung
- mehrsprachige verarbeitung
- mehrsprachigkeit
- mehrsprachunterstützung
- mehrstufige manipulation
- meilenstein:
- meilensteine
- meinmagenta app
- meinungsbeeinflussung
- meinungsfreiheit
- meistern:
- meistert
- meisterwerk
- mensch
- mensch-computer-interaktion
- mensch-gegen-maschine-duell
- mensch-ki-interaktion
- mensch-ki-kollaboration
- mensch-ki-zusammenarbeit
- mensch-maschine-interaktion
- mensch-maschine-kollaboration
- mensch-roboter-interaktion
- mensch-roboter-zusammenarbeit
- Menscheit
- menschen
- menschenähnliche bewegungen
- menschenähnlichen
- menschenverstand
- menschenwürde
- menschenzentrierte ki
- menschheit
- menschliche
- menschliche aufsicht
- menschliche eigenheiten
- menschliche evolution
- Menschliche Intelligenz
- menschliche kognition
- menschliche kontrolle
- menschliche kontrolle über ki
- menschliche sprachnuancen
- menschliche Verbindungen
- menschliche werte
- menschliche würde
- menschlichem
- menschlichen
- menschlicher
- menschlicher beitrag
- menschliches
- menschliches bewusstsein
- menschliches design
- menschliches einfühlungsvermögen
- mention
- mentoring in softwareentwicklung
- Merge Labs
- merkmale,
- mesh-generator
- messenger-integration
- meta
- Meta AI
- Meta Forschung
- Meta KI
- meta ki-chip
- Meta Technologie
- meta training and inference accelerator
- meta und oakley
- Meta Vision
- Meta-Dokumente
- meta-entscheidung
- Meta-Learning
- Meta-Lernen
- meta-lernmechanismen
- meta-sprach-ki
- meta-technologie
- meta-übernahme
- Metallkühltechnologie
- metas
- metas innovation
- Metas KI-Abteilung
- metas prometheus
- metas ray-ban
- metas superintelligenz-abteilung
- meteorologische innovationen
- methode
- methoden,
- methodischer problemlösungsansatz
- michael
- Mico
- microsoft
- microsoft 365
- Microsoft 365 Copilot
- Microsoft AI
- microsoft aurora-ki
- microsoft azure
- microsoft bing
- microsoft build 2025
- microsoft copilot
- microsoft debug-gym
- microsoft dragon copilot
- Microsoft Edge
- microsoft forschungsinvestition
- microsoft graph
- microsoft ki
- microsoft ki-gesundheitsassistent
- microsoft ki-tool
- Microsoft Markt
- microsoft translator
- Microsoft VibeVoice
- Microsoft Vision
- microsoft-forschung
- microsoft-ingenieur
- microsoft-partnerschaft
- microsoft-sicherheitsmaßnahmen
- microsoft-technologie
- microsofts
- Mid Journey
- midjourney
- Midjourney v5
- MidJourney V5.1
- midjourney v7
- Mikrofluidik
- Mikrometeoriten
- mikroplastik-zersetzung
- Mikroroboter
- militär-zivil-fusion
- militär,
- militärische
- militärische forschungsförderung
- militärische ki-anwendungen
- militärische strategie
- millionen
- minderwertigen
- mindestens
- mindstudio
- minecraft
- Mini-Atomreaktoren
- mini-personen
- mini:
- minigehirne
- minimale modelländerungen
- minute
- Mira Murati
- mira murati interims-ceo
- Missbrauch
- missbrauch von ki
- missbräuchliche Chats
- mission
- Missverständnisse lösen
- mistral
- Mistral AI
- mistral le chat
- mistral-small-24b-instruct-2501
- mistral’s
- mit
- mit ai laboratory
- mit KI verdienen
- mit-forscher
- mit-kontroverse
- mit-lizenz
- mitarbeiterengagement
- mitarbeiterkompetenzen
- mitarbeiterkultur
- Mitarbeiterleistung
- mitarbeiterprotest
- Mitarbeiterschulung
- mitarbeiterunmut bei google
- mitose
- mittelklasse-smartphones
- mittelständische unternehmen
- mittelzuweisung
- mixed-reality-gerät
- Mixo
- mixture-of-experts
- ml-fachwissen
- mlx
- mmlu
- mmlu-pro
- möbel
- mobile content-erstellung
- mobile funktionalität
- mobile ki-anwendungen
- mobile kommunikation
- mobile suche
- mobile zugänglichkeit
- mobilediffusion
- mobiles einkaufen
- mode
- mode-regulierung
- modefotografie
- modeindustrie
- modeinnovation
- model
- model poisoning
- model scope
- modell
- modell-effizienz
- modellaktualisierung
- modellauswahl
- Modellbewertung
- modelldiebstahl
- modelle
- modellentwicklung
- modellfunktionen
- modellgeneralisation
- modellgewichte
- modellierung
- modellkollaps
- modellkonvergenz
- modelloptimierung
- modellrisikomanagement
- modells
- modellsicherheit
- modellstabilität
- modelltraining
- modelltransparenz
- modellvergiftung
- modellvergleich
- modellwahrscheinlichkeit
- modellzuverlässigkeit
- models:
- modelscope
- modemarketing
- moderne
- moderne einsamkeit
- MoE-Modell
- mögliche
- möglichkeiten
- molekulare biotechnologie
- molekulare synthese
- Molekulargeometrie
- molekularsimulationsdatensatz
- momentaufnahme
- MONA
- monate
- monatliche einnahmen
- monetarisierung
- monetarisierung von ki-agenten
- mongodb
- monroe
- Monte Carlo Tree Search
- mood boards
- moonvalley
- mooreschen
- Mooresches Gesetz
- moralische verpflichtungen
- moralischer kompass der ki
- moravec-paradoxon
- morgen
- morse-code
- mosaicml:
- motion capture technologie
- motion-design-elemente
- motorische fähigkeiten
- motorola razr
- MrBeast
- mrt-bildqualität:
- mühelose
- Mukesh Ambani
- multi-agent-systeme
- multi-agenten-frameworks
- multi-agenten-struktur
- multi-agenten-systeme
- multi-ai-gruppenchats
- multi-channel-marketing
- multi-head latent attention
- multi-head latente aufmerksamkeitsmechanismen
- multi-instanz-unterstützung
- multi-llm-agenten
- multi-milliarden-dollar-investition:
- multi-modell-ki-integration
- multi-motion-brush-technologie
- multi-omics-ansatz
- multi-plattform-verfügbarkeit
- multi-tasking
- multi-token prediction
- multi-token-vorhersage
- multi-view-diffusion
- multiagenten-systeme
- multifunktionaler
- multilinguale
- multimedia im unterricht
- multimedia-entertainment
- multimediale notizenintegration
- multimodale architektur
- multimodale ausgaben
- multimodale datenverarbeitung
- multimodale eingaben
- multimodale fähigkeiten
- multimodale funktionalität
- multimodale funktionen
- multimodale interaktion
- multimodale ki
- multimodale plattform
- multimodale systeme
- multimodale unterstützung
- multimodale verarbeitung
- multimodale wahrnehmung
- multimodalen
- multimodales sprachmodell
- multimodales sucherlebnis
- multimodales verständnis
- multimodalität
- multispektrale datenanalyse
- multitasking-einschränkungen
- multitasking-probleme
- MultiverseGPT
- Murf
- muse-tool
- museums-qualität
- museumsausstellung
- music
- musicgen
- MusicLM
- musik-app
- musik-mastering-branche
- musik-streaming-technologie
- musikalische zusammenarbeit
- musikalischer protest
- Musikgenerator
- musikindustrie
- musikindustrie innovation
- musikindustrie revolution
- musikintegration
- musikproduktion
- musikverlage
- musikvideo-einnahmen
- Musk
- musk ki-modell
- musks
- müssen
- musst
- mustererkennung
- mutigen
- mütterliche Instinkte
- mycin
- myopic optimization
- mysteriöses
- mystizismus und technologie
- mythos
- nachahmung
- nachfrage:
- nachhaltige
- nachhaltige energie
- nachhaltige ki-anwendungen
- nachhaltige ki-entwicklung
- Nachhaltige Kosmetik
- nachhaltige lieferketten
- nachhaltige schönheitsprodukte
- nachhaltige technologie
- nachhaltige technologien
- nachhaltigkeit in der technologie
- nachrichten
- Nachrichten über KI
- nachrichtendienst
- nachrichtenwebsites
- nachrichtenzusammenfassungen
- nächster
- nachweis von edelmetallen
- nacktbilder
- nahtlose remote-zusammenarbeit
- nahtloses
- Nano Banana
- nano-motor
- Nanopartikel
- narrative fluidität
- narrative innovation
- narwal
- NASA
- nasdaq-100
- nationale
- nationale akademie für ki-unterricht
- nationale sicherheit
- nationale sicherheitsinteressen
- nationales ki-zentrum
- Nationalität
- native bilderzeugung
- native werkzeugintegration
- nato-ki-system
- natur
- nature zeitschrift
- Naturklänge
- natürliche
- natürliche dialogfähigkeiten
- natürliche Gespräche
- natürliche gestenlernen
- natürliche konversation
- natürliche sprachverarbeitung
- natürliche textgenerierung
- natürlichsprachliche interaktion
- naturschutz
- navigation
- navigation in räumen
- navigieren
- nazca-linien
- nazi-ideologie
- negative
- neo gamma
- Neon App
- netflix
- netflix upgrade
- network state bewegung
- netzwerk-chips
- netzwerkfähigkeiten
- Neu-Delhi
- neu:
- neuartige
- neuartige enzyme
- neuartiger
- neuausrichtung:
- neubeginn
- neudefinition
- neue Fragen
- neue Funktionen
- neue geschäftsmodelle
- Neue Jobs
- neue Strategie
- neuer
- neues
- neueste
- Neueste Entwicklungen
- neuestem
- neuesten
- neuigkeiten
- neural-prozessoren
- neurale schnittstellen
- neuralgcm
- Neuralink
- neuraltechnologie
- neuronale effizienz
- neuronale integration
- neuronale kommunikationstechnologie
- neuronale maschinelle übersetzung
- neuronale Netze
- neuronale netzwerke
- neuronale plastizität
- neuronale signale
- neuronale verarbeitungseinheiten
- neuronen-gesteuertes rechnen
- neurotechnologie
- neurowissenschaft
- neuschreibung menschlichen wissens
- neuste
- neutraler plattformaufbau
- new york times
- news
- next.js
- Nextgenai
- nicht-invasive diagnose
- nicht-invasive therapie
- nicht-programmierer
- niedlichkeitsstrategie
- niedrige kosten
- niedrige latenzzeiten
- nightcafe
- nightshade:
- niji
- Niji-Parameter
- nimmt
- niveau
- nixl-kommunikationsbibliothek
- nlp
- no-code-app-builder
- no-code-plattform
- no-code-plattformen
- no-code-tools
- no-logs-richtlinie
- noch?
- non-myopic approval
- nonprofit-organisation
- norbert wiener
- normalen
- Nostalgie
- nostalgie,
- nostalgische ästhetik
- notbremse:
- NotebookLM
- Notebooklm Plus
- Notfall-AMA
- notion
- Notion AI
- nova act
- nova-modus
- november
- npu-chip
- nsfw-bilder
- nsfw-inhalten
- nuancen
- nuancierte übersetzungslösungen
- nukleartechnik
- nutzen
- nutzer-feedback
- nutzerbasis
- nutzerbeschwerden
- nutzerbindung
- nutzerdaten
- nutzerdatenanalyse
- nutzerdatenspeicherung
- nutzereinwilligung
- nutzerengagement
- nutzererfahrung
- nutzererfahrung verbessern
- nutzererfahrungen
- nutzererlebnis
- nutzererwartungen
- nutzerfeedback
- nutzeridentität
- nutzerinteraktion
- nutzerinteraktionsmuster
- nutzerkontrolle
- nutzern
- nutzerprivatsphäre
- Nutzerproteste
- nutzerschutz
- nutzersicherheit
- nutzerverhalten
- nutzerverhalten-analyse
- nutzerverständnis
- nutzerwachstum
- nutztierhaltung
- nutzung
- nutzung von ki-modellressourcen
- nvidia
- nvidia a100 gpus
- nvidia dynamo
- nvidia gr00t n1.5
- nvidia h100 chips
- nvidia h100 gpu
- nvidia h800
- nvidia h800-chips
- nvidia in europa
- nvidia ki-innovationen
- nvidia omniverse
- nvidia rtx 4090
- nvidia unterstützung
- nvidia-hardware
- nvidia-stanford-zusammenarbeit
- nvidia-Übernahme
- nvidias
- Nvidias Cosmos
- nvlink fusion
- o1-preview
- o1-pro
- O1-Pruner
- O3-Mini
- o3-mini modell
- O3-Mini-Modelle
- o3-serie
- oberlandesgericht frankfurt
- objective-c
- objekten
- objekterkennung
- objektivempfehlungen
- objektmanipulation
- Observability
- ocr-technologie
- oder
- odysseys
- offenbart
- offene wissenschaft
- offenen
- offener marktplatz
- offenheit in ki-gesprächen
- öffentlich-private zusammenarbeit
- öffentliche
- öffentliche aufsicht
- öffentliche meinung
- öffentliche politik
- öffentliche reaktion
- öffentliche wahrnehmung
- öffentlicher nutzen
- öffentlicher sektor
- öffentliches
- öffentliches vertrauen
- öffentliches vertrauen in ki
- Öffentlichkeit
- Office 365
- offline-funktionalität
- offline-ki
- Offline-Verarbeitung
- ominöse
- omnibooth
- on-device-lernen
- On-Device-Limitierungen
- on-device-verarbeitung
- on-premises-installation
- onboarding-system
- onkologie
- Online
- Online Bedrohungen
- Online Casino
- online-bilderzeuger
- online-casinos
- online-communities
- online-community
- online-community-löschung
- online-dating
- online-datings:
- online-einkauf
- online-erfolg
- online-freiberufler
- online-freiheit und autonomie
- online-geldverdienen
- online-gemeinschaften
- Online-Handel
- Online-Inhalte
- online-manipulation
- online-pokers:
- online-quellenanalyse
- online-regulierung
- Online-Shopping
- online-shopping-innovation
- online-storefront-automatisierung
- Online-Suchen
- online-videoumgebung
- online-werbeveränderungen
- Online-Werbung
- online-wirtschaft
- open
- open apache 2.0-lizenz
- open source
- open web
- Open-Source
- Open-Source Framework
- Open-Source Modelle
- open-source-algorithmus
- open-source-chatbot
- open-source-codiermodellen
- open-source-forschung
- open-source-initiative
- open-source-initiativen
- open-source-ki
- open-source-ki-agenten
- open-source-ki-modelle
- open-source-ki-tools
- open-source-lizenz
- open-source-lösungen
- open-source-modell
- open-source-modelle
- open-source-musikproduktion
- open-source-plattform
- open-source-plattformen
- open-source-projekte
- open-source-sprachmodell
- open-source-technologie
- open-source-technologien
- open-source-tool
- open-source-tools
- open-source-tts
- Open-Weights-Modell
- OpenAI
- openai api
- openai deep research
- openai for government
- openai führungswechsel
- openai gegen google chrome
- openai gegen meta
- openai gpt 4.5 orion
- openai hardware
- openai integration
- openai japan
- openai kauft chrome
- openai o3-mini
- openai operator
- openai partnerschaft
- openai partnerschaft vae
- openai stargate-projekt
- openai übernahme
- openai und microsoft
- openai updates
- openai webbrowser
- openai-ceo
- openai-microsoft
- openai-microsoft-partnerschaft
- openai-modelle
- openai-partnerschaften
- openais
- openais wandel
- openelm:
- Openrouter
- opera
- Opera Browser
- opera neon
- operationalisierung
- operationen:
- operative effizienz
- Operator
- operator ai-assistent
- operator ki-agent
- opfertäuschung
- opt-out-system
- opt-out-verfahren
- optimale Ergebnisse
- optimieren:
- optimiert
- optimierte
- optimierter
- optimiertes
- optimierung
- optimierung von arbeitsabläufen
- optimierung von ki-code
- optimierungstechniken
- optimierungsverfahren
- Optimismusverlust
- optimum
- option
- oracle
- organisationen
- organischer traffic
- Organisierte Gespräche
- orientierung
- origami-falten
- originale inhalte
- orion
- ork
- ork-bars:
- oscar-regeln
- ostern
- outlook-ansicht
- outsystems
- overfitting
- overfitting-reduktion
- overflow’s
- oxford university
- oxolo
- ozempic
- packt
- paint
- painting
- paketsortierung
- palantir
- palantir technologies
- palm
- Palo Alto Networks
- Pandemievorbereitung
- papierband
- papierstauvermeidung
- papst leo xiv.
- Parag Agrawal
- parallele verarbeitung
- parameterbereich
- paris
- parry
- parser-systeme
- parteipolitische unterschiede
- partizipativer prozess
- partner
- partnerschaft
- partnerschaft mit nvidia
- partnerschaften
- Partnerwahl
- passives einkommen
- patentübernahme
- patientenautonomie
- patientenberatungs-dashboard
- patientendaten
- patientendatensicherheit
- patientendokumentation
- patientensicherheit
- patientenversorgung
- patri friedman
- paul mccartney
- pay-as-you-go-modell
- pay-per-crawl-marktplatz
- pay-per-token
- pcs
- pdf-dokumente
- pdf-interaktion
- Peer-Review
- peer-review-prozess
- peer-review-studie
- Penalizierungen
- pentagon-vertrag
- perceptron
- performances
- perplexity
- Perplexity AI
- perplexity labs
- perplexity max-plan
- persona-attribute
- personal
- personalabbau
- personalisierte avatare
- personalisierte benutzeroberfläche
- personalisierte bildung
- personalisierte einkaufsempfehlungen
- personalisierte einkaufserfahrung
- personalisierte empfehlungen
- personalisierte größenempfehlungen
- personalisierte hautpflege
- personalisierte interaktion
- personalisierte ki-unterstützung
- personalisierte krebsbehandlung
- personalisierte lernerfahrungen
- personalisierte lernhilfen
- personalisierte matches
- personalisierte medizin
- personalisierte nutzererfahrung
- personalisierte produktempfehlungen
- personalisierte sucherlebnisse
- personalisierte tools
- personalisierte verbindungen
- personalisierte wellness-empfehlungen
- personalisierten
- personalisierter behandlungsplan
- Personalisierung
- personalisierungseinstellungen
- personalisierungsfunktionen
- personalisierungsparameter
- personalkürzungen
- personalmanagement
- personalstrategie
- personenbezogene daten
- persönliche
- persönliche identität
- persönliche note
- persönliche produktivität
- persönlicher ton
- persönlichkeit
- Persönlichkeits-Engineering
- persönlichkeitserkennung
- Persönlichkeitsprofilierung
- peter thiel
- Pharmabranche
- pharmazeutische entwicklung
- phasenübergänge
- phd-level ki
- phgdh-gen
- phi-3
- phillips’
- philosophische fragen der ki
- Phishing Schutz
- phishing-bedrohungen
- phishing-e-mails
- phishing-kampagnen
- phonetische interpretation
- photo
- photomaker
- Photoshop
- physik
- physikalisches
- physiklernen
- physiksimulation
- physische interaktion
- physische KI
- picsart
- pile
- pimeyes
- pinup-illustration
- pionier
- pionierarbeit
- pipa
- piraterie
- Pixel 10
- Pixel 9a
- pixtral
- Plagiate
- plagiatserkennung
- plagt
- plan
- pläne
- Plattenlabel
- plattform
- plattform outlier
- plattform-engagement
- plattform-glaubwürdigkeit
- plattform-innovation
- plattform-integration
- plattform-risiken
- plattform-transparenz
- plattform-vereinheitlichung
- plattform-zugänglichkeit
- plattformintegration
- Plattformkontrolle
- plattformübergreifende datensammlung
- plattformübergreifende entwicklung
- plattformübergreifende integration
- plattformübergreifende verfügbarkeit
- plattformunabhängiges design
- plattformverlagerung
- pld3-enzym-dysfunktion
- plugin store
- plugin-installationen
- Plugins
- plugins von drittanbietern
- plus-abo
- pokémon-experiment
- politik
- politische entscheidungsträger
- politische führung
- politische inhaltsmanipulation
- politische Manipulation
- politische maßnahmen
- politische neutralität
- politische prozesse
- politischen
- politischer diskurs
- politischer wandel deutschland
- polymorphe malware
- portrait
- portraits
- porträts:
- position
- posteingang:
- posten
- postgresql
- postings
- potenzial
- Potenzial freisetzen
- potenziale
- potenzials
- potenzieller
- power
- power-user
- powertoys
- prädiktive analysen
- prädiktive analytik
- prädiktive systeme
- prädiktive wartung
- präferenzoptimierung
- präkolumbianische zivilisationen
- praktische anwendungen
- praktische mathematikanwendung
- präsentation
- präsentiert
- präventive gesundheitsfürsorge
- präventivmedizin
- präzedenzfall
- präzise anpassungen
- präzisionsmedizin
- predictive analytics
- preis-leistungs-verhältnis
- preisgestaltung
- preisgünstige technologie
- preiskrieg
- preisreduktion
- preisstrategie
- preisstruktur
- premiere
- premium-abonnement
- premium-nutzer
- premium-pläne
- premium-preis
- premium-preisstruktur
- premium-service
- presidio
- pretraining
- priesterin
- prime-versandvorteile
- prinzipien
- prithvi-wetter-klima-modell
- privatängste:
- private evolution
- privatsphäre
- privatsphäre bedenken
- proaktive maßnahmen
- proaktive nachrichten
- probabilistische vorhersagen
- probleme
- problemlösung
- problemlösungsalgorithmen
- problemlösungsszenarien
- product
- produkt-
- produktdesign
- produkte
- produkten
- produktentwicklung
- produktionssektor
- produktiver
- produktivität
- Produktivität verbessern
- produktivitätssoftware
- produktivitätssteigerung
- produktivitätsverbesserungen
- produktkonsolidierung
- produktplatzierung
- produktvergleiche
- produktvision
- produktvisualisierung:
- produktzuverlässigkeit
- professionelle bildmanipulation
- professionelle designwerkzeuge
- professionelle fotografie
- Professionelle Inhalte
- professionelle nutzung
- professionelle produktionen
- professionelle produktionsstandards
- professionelle videoproduktion
- professionelle visualisierungen
- professionelles design
- profis
- profitabler
- prognosegenauigkeit
- programme
- programmierassistent
- programmieraufgaben
- Programmierbewertungen
- Programmieren
- programmierfähigkeiten
- programmierfrei
- programmiergenauigkeit
- programmiergeschichte
- Programmiergeschwindigkeit
- programmierherausforderungen
- programmierhilfe
- programmierproduktivität.
- programmierprojekte
- programmierskills
- programmiersprachen
- programmierung
- programmierung in python
- programmierungsaufgaben
- prohormon-convertase
- project
- projekt astra
- projekt mac
- projekt mariner
- Projekt Prometheus
- projektbasiertes lernen
- Promi-Stimmen
- prominente
- Prompt
- Prompt Engineering
- Prompt Kurs
- prompt-engineering-kurse
- prompt-injection-angriffen
- Prompt-Injektionen
- Prompt-Optimierung
- Prompt-Technik
- prompt-techniken
- prompte
- promptfantasy
- prompting
- Prompting-Funktionen
- Prompting-Methoden
- prompts
- promt
- propagandaverbreitung
- proprietäre software
- prosecraft-kontroverse:
- prostatakrebs
- prostatakrebs-erkennung
- prostatakrebs-screening
- prostatakrebs-subtypen
- protecting
- protein-design
- protein-engineering
- protein-evolution
- Protein-KI
- protein-strukturvorhersage
- proteinablagerungen
- proteinstrukturanalyse
- proteinstrukturen
- proteinstrukturvorhersage
- proteomik
- Protokollierungsfehler
- proton
- prototyping
- prozedurale terrains
- prozessautomatisierung
- prozessoptimierung
- prozesssimulation
- prüfe
- prüfstand:
- psa-test
- psychiater
- psychische
- psychische Gesundheit
- psychologische manipulation
- psychologische unterstützung
- public benefit corporation
- publikationsstandards
- publikumsengagement
- publisher schutz
- Pulse-Funktion
- pulse:
- punk
- push:
- putins
- pwc zusammenarbeit
- python-code
- python-programmierung
- q-learning
- q*-algorithmus:
- Quake II
- Qualcomm
- qualia
- qualität
- qualität der antworten
- qualitativ hochwertige matches
- qualitätskontrolle
- qualitätssicherung
- qualitätssicherung in der entwicklung
- qualitätsstandards
- quantenbewusstsein
- Quantencomputer
- quantencomputing
- quantendiplomatie
- quantenfehlerkorrektur
- quantenfortschritte
- quantenkühlungsexperimente
- quantenmaterialien
- quantenphysik
- Quantenprozessoren
- quantensichere kryptografie
- quantensichere verschlüsselung
- quantenüberlegenheit
- quantum computing
- Quasar Alpha
- qubit-stabilität
- qubits
- quellenüberprüfung
- query fan-out-technik
- qwen 2.5-max
- qwen2.5-omni
- qwen3
- Qwen3-Max
- qwq-32b
- r1-v
- R2-Agent
- rabatt
- rachsüchtige
- racing
- radiologen
- radiologie
- rag-as-a-service
- ram-beschränkungen
- ram-management
- rampenlicht:
- random
- randomisierung
- rang
- ranking
- ransomware-angriffe
- rassendiskriminierungsvorwürfe
- rassismus in technologie
- rassistische voreingenommenheit
- rauchmusteranalyse
- raucht
- rauchverhalten
- räumliche Generierung
- räumliche Intelligenz
- räumlicher computer
- räumliches audio
- räumliches denken
- räumliches verständnis
- raumschiff
- ray-ban
- react-code-vorschau
- reaktionen
- reaktionszeiten verbessern
- real,
- realen
- realismus in ki
- realistische
- realistische bewegungen
- realistische bilder
- realistische kleidungssimulation
- realität
- realitäten
- reality
- reasoning slider
- reasoning-fähigkeiten
- reasoning-modelle
- recheneffizienz
- rechenkapazitäten
- Rechenkosten
- rechenleistung
- Rechenorchestrierung
- rechenressourcen
- rechenschaftspflicht in der ki
- rechenzentren
- Rechenzentrum
- rechenzentrumskosten
- rechte
- rechtliche
- rechtliche aspekte
- rechtliche auseinandersetzung
- rechtliche auseinandersetzungen
- rechtliche compliance
- rechtliche dokumentenanalyse
- rechtliche effizienz
- rechtliche forderungen
- rechtliche herausforderungen
- rechtliche rahmenbedingungen
- rechtliche Schritte
- rechtliche technologie
- rechtliche überlegungen
- rechtliche verpflichtungen
- rechtlichen
- rechtsdatenbanken zur quellenprüfung
- rechtslage
- rechtspräzedenzfall
- Rechtsprozess
- rechtsstreit
- rechtsverletzungen
- red teaming
- redaktion
- reddit-experiment
- reduktion von explorationskosten
- redundantes
- reduziert
- reduzierung von verwaltungsaufwand
- reelmagic
- referenzbilder
- reformiert:
- regelbasierte systeme
- regelbasiertes computing
- regeln
- regierungsbehörde
- regierungseffizienz
- Regierungsforschung
- regierungsoperationen
- regierungsvorschriften
- regularisierungsstärke
- regulatorische
- regulatorische anforderungen
- regulatorische aufmerksamkeit
- regulatorische aufsicht
- regulatorische compliance
- regulatorische einschränkungen
- regulatorische hürden
- regulatorische konformität
- regulatorische rahmenbedingungen
- regulatorische richtlinien
- regulatorischer druck
- regulatory intelligence office
- regulieren?
- Regulierung
- regulierung von ki
- regulierungsbehörde
- regulierungsforderungen
- regulierungsfragen
- regulierungsmaßnahmen
- reid hoffman
- reinforcement
- Reinforcement Learning
- reinforcement learning from human feedback
- reinforcement learning with human feedback
- reise-
- reisebeschränkungen
- reisebuchung
- reiseführer
- Reisen
- rekordzeit
- rekrutierungskampf
- rekrutierungsstrategien
- rekurrente neuronale netzwerke
- rekursive funktionen
- Reliance Jio
- religiöse technologie
- remote-arbeit
- rennen
- renovierung
- rentabilitätsziel
- reparieren
- repertoire
- replit
- Resemble
- responses api
- ressourceneffizienz
- ressourcenverbrauch
- restaurantreservierungen
- retrieval-augmented generation
- Rettungspaket
- revolution
- revolutionäre
- revolutionärer
- revolutionieren
- revolutioniert
- revolutionierung
- rfid-tracking
- Richard Kadrey
- richterin yvonne gonzalez rogers
- richtig
- richtigen
- richtlinien
- richtlinienverstöße
- ring-türklingeln
- Risiken
- risiken der ki-autonomie
- risiken durch ki-halluzinationen
- risiko
- risikobeurteilung
- risikobewertung
- risikoerkennung
- risikokapital
- risikokapital deutschland
- risikokapitalfirmen
- risikomanagement
- rite
- rivale
- rna-virosphäre
- robby der roboter
- Robin Williams
- Roblox
- robo-berater
- robocall-betrug
- robotaxis
- robotaxis in london
- roboter
- roboter in der fertigung
- roboter in filmen
- roboter-emotionen
- roboter-geschicklichkeit
- roboter-rituale
- roboter-trainingsmethoden
- roboter-wettkampf
- roboterautomatisierung
- roboterflotte
- robotergestützte chirurgie
- roboterhandschuh
- roboterlernprozess
- robotern
- roboterrevolution
- robotertechnologie
- robotertraining
- roboterwartung
- robotik
- robotik 1960er
- robotik-innovation
- robotik-innovationen
- robotik-innovationsagenda
- robotik-software
- robotik-technologie
- robotikinnovation
- robotiklabor
- robotisches lernen
- robuste ki-modelle
- robuste sicherheitsmaßnahmen
- robustheit des modells
- robustheit in ki
- rocken
- rocket-1
- rogerianischer psychotherapeut
- roi von ki
- rolle
- rolle von ki in der technologie
- Rolls-Royce
- romance
- romantische Gefühle
- rotationsdynamik
- roter
- routineuntersuchungen
- rpm youtube
- rtx 4090
- rtx remix
- rückeroberung
- rückkehr
- rückkopplungssysteme
- rücktritt
- rücktrittsforderungen
- run:ai.
- runway gen-4
- runway integration
- ruoming pang
- rust
- rüstung:
- Söder
- sachbüchern
- safe superintelligence
- safety
- saga
- sakana ai
- salesforce
- sam
- Sam Altman
- sam altman abgang
- sam altmans vorhersage
- sam2long
- samsung
- Samsung Fernseher
- samsung galaxy a-serie
- samsung perplexity integration
- sanfte
- sap
- sapiens
- sarah
- Sarah Silverman
- sarkasmus-erkennung
- satellitenbilder
- satellitendaten-analyse
- satellitendatenanalyse
- satellitenkonstellation
- Satellitentechnologie
- satire
- saubere energie
- saudi vision 2030
- saudi-arabiens
- scale ai
- scams
- scarlett
- scarlett johansson
- schach-ki
- schachcomputer
- schaffen
- schaffung neuer arbeitsplätze
- Schamanin
- scharf,
- schärfer,
- schatten
- Schattenbibliotheken
- schattenseiten
- schauspieler:
- schicksals
- schlafen
- schlag
- schlaganfallüberlebenden
- schlanke
- schließt
- Schlösser
- schlug
- schluss
- schlüssel
- schlüsselwort-steuerung
- schmauchspuren
- schmerz
- schnelldurchlauf:
- schnelle antworten
- schnelle identifikation von mineralien
- schnelle produktionszeit
- schnelle rendergeschwindigkeit
- schneller
- schnittpunkt
- schnittstelle
- scholar
- Scholar Labs
- scholz’
- schöne
- schönheitswettbewerb:
- schöpfen
- schöpferischen
- schränkt
- schreibbranche
- schreibe
- Schreiben
- schreibstil
- schreibt
- schreibwerkzeuge
- schriftrollen
- schriftstellerisches
- schritt
- schrittweise argumentation
- schulen
- schüler mit behinderungen
- schülern,
- schulungsprogramme
- schutz
- schutz der demokratie
- schutz kreativer rechte
- schutz vor ki-missbrauch
- schützt
- schwachstellen
- schwachstellenanalyse
- schwachstellenbewertung
- schwachstellentests
- schwarmtechnologie
- schwarzer
- Schwarzes Loch
- schwebende
- schwert
- schwierigkeiten,
- science-fiction der 1970er
- science-fiction-filme
- scout modell
- scrapeowl
- screening-werkzeuge
- screenspot pro benchmark
- scribe:
- seamlessm4t
- seamlessm4t-modell
- search labs
- searchgpt:
- seasteading institute
- sebastian thrun
- sec’s
- sechs
- seed
- Seed Prompting
- seed-finanzierung
- seelen
- segelschiff
- sehbehinderung
- sehen:
- seitenverhältnis
- selbstfahrende autos
- selbstheilende materialien
- selbsthilfebuch
- selbstmodifikation
- selbstmodifizierende systeme
- selbstmord
- selbstreflexion
- selbstüberwachtes
- select
- seltene erden
- semantische netzwerke
- semantische segmentierung
- semantischer audio-tokenisierer
- Semrush
- senat
- senatsanhörung
- sensible benutzerdaten
- sensible bundesdaten
- sensible inhalte
- sensor-array
- SensorLM
- seo
- seo-content-erstellung
- seo-content-tool
- seo-optimierten
- seo-optimierung
- SEO-Richtlinien
- seo-strategie
- server-optimierung
- serverabschaltung
- service
- servicequalität
- sesame startup
- setzen
- setzt
- sexy
- sexy KI-Roboter
- SGE
- shakey
- shakey der roboter
- shane legg
- Sheet+
- shenzhen startup
- shift:
- shiseido
- shop-builder-tool
- shopify
- shopify ki-integration
- shopify magic
- shopifys ki-strategie
- ShortLyAI
- shorts
- shoutcart
- showrunner
- shows
- sich
- sichelzellenanämie
- sicher?
- sichere datenübertragung
- sichere technologie
- sichere verarbeitung
- sicherer
- sicherheit
- sicherheit im internet
- sicherheit in spracherkennung
- sicherheit und compliance
- sicherheitsbedenken
- sicherheitsbewertung
- sicherheitsdaten
- sicherheitsdaten-veröffentlichung
- sicherheitsforschung
- sicherheitsframeworks
- sicherheitsfunktionen
- sicherheitslücken
- sicherheitsmaßnahmen
- sicherheitsmetriken
- Sicherheitspraktiken
- sicherheitsprotokolle
- sicherheitsprotokolle für patientendaten
- sicherheitsrahmen
- sicherheitsrahmenwerke
- sicherheitsrelevante
- sicherheitsrisiken
- sicherheitsstandards
- sicherheitsstandards in ki
- sicherheitssysteme
- sicherheitstechnologie
- sicherheitsupdates
- sicherheitsverbesserungen macos
- sicherheitsvorfall
- Sicherheitswarnungen
- Sicherheitszonen
- sicherstellen
- sichert
- sichtweise
- sie
- sieht
- siglip-l vision encoder
- signalfire
- signaturen
- silhouette
- silicon
- silicon engineering
- silicon one asics
- silicon superintelligence initiative
- silicon valley
- silicon-valley-spiritualismus
- silizium-technologie
- silverman
- Silvester
- Silvesterfeier
- silvesternacht
- sima:
- simulation evolutionärer prozesse
- simulationsagenten
- Simulationsherausforderungen
- simulationswerkzeuge
- simulive webinar
- sind
- sinken.
- Sinne
- siri
- siri sprachsteuerung
- siri upgrade
- siri verbesserungen
- siri-integration
- situation
- sitzt
- skalierbare ki-systeme
- skalierbarkeit
- skild
- skizzen
- skulpturen
- Slack
- slash-befehle
- Small 3
- smart
- smart city
- smart ev
- smart glasses
- Smart Home
- smart manufacturing
- Smart-Brille
- smart-device-markt
- smart-glasses-entwicklung
- smart-home-funktionalitäten
- smart-home-integration
- smart-home-technologie
- smartphone
- Smartphone Innovation
- Smartphone-Gebrauch
- smartphone-innovation
- smartphone-markt
- smartphone-technologie
- smartphones
- smartphones 2025
- SmolVLM2
- Snapchat
- snapchat ad lenses
- snapdragon 7 gen 2
- Snapdragon 8 Elite
- snarc
- snowflake
- social
- social engineering
- social media
- social media integration
- social-media-clips
- social-media-marketing
- social-media-plattformen
- social-media-sicherheit
- söder’s
- sofortige übersetzung
- sofortigen
- softbank
- software-development-kit
- software-engineering
- software-entwicklung:
- software-entwicklungs-kits
- software-optimierung
- software-updates
- softwareentwicklung
- softwareentwicklungszyklus
- softwareerstellung
- sokratische methode
- sokratische Weisheit
- solarenergie
- solarfarmen
- solarium design
- sollten!
- sonderwirtschaftszonen
- Songgenerierung
- songtexte
- Sonnenstürme
- sonnet:
- sora ai
- sora-integration
- sora:
- Sorayama
- soundslice
- source
- souveräne ki
- soziale erfüllung
- soziale herausforderungen
- soziale Interaktion
- soziale medien
- soziale medien interaktion
- soziale medienplattformen
- soziale netzwerke
- sozialen
- sozialer kontext
- soziales modeerlebnis
- sozialleistungsverteilung
- space
- space marine
- spam-richtlinien
- spanisch
- spanisches
- spanischsprachige
- spannende
- spannungsfeld
- sparen
- sparsame aufmerksamkeit
- sparse-modellen
- spatial computing
- spectrum-x-plattform
- Speech-To-Text
- speed-running
- speicherknappheit
- speichers
- speicherverwaltung
- spekulationen
- sperrung
- spezialisierte funktionen
- spezialisierte hardware
- spezialisierte ki-hardware
- spezialisierung
- spezifikationen
- Spiele
- spieleentwicklung
- spieleindustrie
- spielen
- spieler,
- spielerähnlichkeit
- spielerlebnis
- Spielstrategie
- spielveränderung
- spintax
- Spionage
- Spirit Me
- spirituelle
- spitzenstartups
- splatt
- spontaneität:
- sportleistung
- sports
- spotify
- spotify-hörer
- spotify-kritik
- Sprach-KI
- Sprachagenten
- sprachanwendungen
- sprachassistent
- sprachassistenten
- sprachassistententechnologie
- sprachassistentin maya
- sprachbarrieren
- sprachbeeinträchtigungen
- Sprachbefehle
- sprachdiktierfunktionen
- sprache
- sprache-zu-text
- spracheingabe
- sprachen
- Sprachenlernen
- Spracherkennung
- spracherkennungsmarkt
- spracherkennungssoftware
- spracherkennungssysteme
- spracherkennungstechnologie
- sprachfähigkeiten
- sprachgenerierung
- sprachgesteuerte
- sprachliche diskriminierung
- sprachliche vielfalt
- sprachliche zugänglichkeit
- Sprachlücken erkennen
- Sprachmodell
- sprachmodell-schwachstellen
- sprachmodelle
- sprachmodellen
- sprachmodus
- sprachmodus innovationen
- sprachmuster-erkennung
- sprachmustererkennung
- sprachnachrichten
- sprachsteuerung
- Sprachstil
- sprachsynthese
- sprachsynthese-technologie
- sprachtechnologie
- sprachübersetzung
- sprachunterstützung
- sprachverarbeitung
- sprachverarbeitungstechnologie
- sprachverständnis
- sprachwiederherstellung
- spreadsheetllm
- sprechen
- sprechererkennung
- sprengt
- spricht
- springerverlag
- spyre accelerator
- spyre ki-beschleuniger
- staatlich
- staatliche autonomie
- staatliche dienstleistungen
- staatliche kontrolle
- staatliche überwachung
- Staatsrechte
- stabilität
- stability
- Stability AI
- stability ai stable virtual camera
- stable
- stable diffusion
- stablecode
- StableLM
- stack
- städte
- Städte Informationen
- städtische mobilität
- stadtpostkarten
- stand-up
- standards
- stanford arm
- Stanford KI
- stanford research institute
- Stanford Studie
- stanford-forschung
- star
- Stargate
- stargate ai
- stargate projekt
- stargate uae
- stargate-ai-projekt
- stargate-initiative
- starke
- stärkung
- start
- start-up
- start-up-finanzierung
- startet
- startup
- startup-akquisition
- startup-bewertung
- startup-finanzierung
- startup-finanzierung ohne eigenkapital
- startup-Ökosystem
- startup-übernahme
- startup-zusammenbruch
- startups
- statistische analyse
- statistische sprachmodelle
- Statsig
- staudämme
- stehen
- steigern
- steigert
- steigerung
- steinrätsel
- stellare dynamik
- stellare physik
- stellen
- stellenausschreibungen
- stellt
- stem-anwendungen
- stereotypen
- sternenausbrüche
- steuerung
- stiehlt
- stigmatisierung
- stil
- stilles album
- Stilrichtlinien
- stimme,
- stimmen
- stimmen-upgrade
- stimmenklonierung
- stimmenklonung
- stimmklon-technologie
- stimmklonierung
- stimmrechte
- stimmungsanalyse
- stoppen
- story-vielfalt
- storys
- storytelling:
- strategie
- strategien
- strategien zur ki-integration
- strategische
- strategische Entscheidungen
- strategische forschungsförderung
- strategische hürde
- strategische partnerschaften
- strategische positionierung
- strategische täuschung
- strategischer Denkpartner
- strategischer unternehmenszug
- strategisches Denken
- strategisches profilmanagement
- strawberry-projekt
- streaming-einnahmen
- streaming-plattformen
- streaming-technologie
- streben
- street
- streik
- stress-testing
- stresserkennung bei tieren
- strichmännchen-videos
- stromabnahmeverträge
- strombedarf
- strombedarf von ki
- strominfrastruktur
- stromverbrauch ki
- strukturierte
- strukturierte daten
- strukturierte datenausgabe
- strukturierter
- strukturiertes Framework
- strukturiertes kritiklernen
- studenten
- Studenten Betrug
- studenteninnovation
- studentenrabatt
- studentenzentrierte schnittstelle
- studie
- studie zu arbeitsauswirkungen
- studio
- Studio Portraits
- studio-ghibli-stil
- stunden
- sturm
- style reference-funktion
- styles
- Such-API
- suchalgorithmus
- suche
- Suchergebnisse
- sucherlebnis
- Suchir Balaji
- suchmaschinen
- suchmaschineninnovation
- suchmaschinenintegration
- suchmaschinenlandschaft
- suchmaschinenmarkt
- suchmaschinenmonopol
- suchmaschinenplatzierung
- Suchtechnologie
- suchverkehrsmuster
- südamerika
- südasien-markt
- südkorea
- südkorea ki-initiative
- Suizid
- suizidprävention
- summit
- supabase
- super mario ki
- super night mode
- super-agenten
- Superbakterien
- supercomputer
- supercomputing
- supergrok-abonnements
- superhelden-beitrag:
- superintelligence labs
- superintelligente KI
- superintelligenz
- Superkeime
- Supernova
- superposition
- supertest
- supervised fine-tuning
- supraleiter
- supraleiter-entdeckung
- supremacyagi,
- Surface
- surfen
- swapping
- swe-bench
- swift
- swiglu-aktivierungsfunktion
- sydney
- symbolische berechnung
- symbolische KI
- symbolische systeme
- symgen
- synonym
- synthetische daten
- synthetische datengenerierung
- synthetischer
- system-design-prinzipien
- systemanforderungen
- systeme
- systemen
- systemintegrität
- systemkompromisse
- systemkonfiguration
- systemoptimierungen
- systemtheorie
- szenen
- szenenkonsistenz
- t2v-14b
- tacticai
- tages
- täglicher Assistent
- tägliches werkzeug
- taiwan
- taiwans
- taktisches
- Talentabwanderung
- talentabwerbung
- talentakquisition
- talentdefizit
- talentgewinnung
- talentkrieg
- taskautomatisierung
- tätig
- tatortanalyse
- tau-bench
- taumeln
- täuschung
- täuschung durch ki
- team-kollaboration
- team-pläne
- teamarbeit
- teamcraft
- teams
- tech
- tech-branche
- tech-fauxpas
- tech-giganten
- tech-giganten-kooperation
- tech-industrie
- tech-investitionen
- tech-investoren
- tech-milliardäre
- tech-schwergewichte
- tech-titanen
- techcrunch
- technik
- techniken
- technikexperten
- technische
- technische analyse
- technische anwendungen
- technische benutzerhürden
- technische berechnungen
- technische beschränkungen
- technische bewertungen
- technische demonstration
- technische dokumentation
- technische effizienz
- technische finesse
- technische funktionen
- technische herausforderungen
- technische implementierung
- technische infrastruktur für ki
- technische innovation
- technische komplexität
- technische leistung
- technische mängel
- technische minderungsstrategien
- technische mitarbeiterausbildung
- technische schulden
- technische schwierigkeiten
- technische support
- technischer fachjargon
- technischer fortschritt
- technischer support
- technisches fachwissen
- technolibertär
- Technologie
- Technologie Auswirkungen
- technologie im bildungswesen
- technologie im gesundheitswesen
- technologie im journalismus
- technologie im klassenzimmer
- technologie im sport
- technologie in der geologie
- technologie in der werbung
- technologie meilenstein
- Technologie Nachrichten
- Technologie News
- Technologie Trends
- technologie und ethik
- technologie und gesellschaft
- technologie und kreativität
- technologie und nostalgie
- technologie und redaktionelle qualität
- technologie-diplomatie
- technologie-eilmeldungen
- technologie-giganten
- technologie-integration
- Technologie-Investition
- technologie-investitionen
- technologie-investoren
- technologie-konkurrenz
- technologie-milliardär
- technologie-sektor
- technologie-skepsis
- technologie-start
- technologieabhängigkeit
- technologieakquisition
- technologieaktien
- technologieakzeptanz
- technologieanbieter
- technologieanwendungen
- technologieausgaben
- technologiebereich aufmerksamkeit
- technologiebranche
- technologiebranche deutschland
- technologiedemokratisierung
- technologiedesign
- technologieeinfluss
- technologieeinführung
- technologieeinsatz
- technologieenttäuschung
- technologieentwicklung
- technologieentwicklung im film
- technologieethik
- technologiefortschritt
- technologieführer
- technologieführerschaft
- technologieführung
- technologiefusion
- technologiegesteuerte regierungsführung
- technologiegigant
- technologiegiganten
- technologieindustrie
- technologieinnovation
- technologieinnovation im web
- technologieinnovationen
- technologieintegration
- technologieinvestition
- technologieinvestitionen
- Technologiekonflikt
- technologiekonvergenz
- technologielandschaft
- technologiemarkt
- technologiemarkt china
- technologiemarktkonsolidierung
- Technologien
- technologienetzwerk
- technologiepartnerschaft
- technologiepartnerschaften
- technologiephilosophie
- technologieplattformen
- technologiepolitik
- technologieprognosen
- technologieriese
- technologieriesen
- technologiesektor:
- technologiesicherheit
- technologietransformation
- technologieübernahme
- technologieüberwachung
- technologieunabhängigkeit
- technologieungleichheit
- technologieunternehmen
- technologieverbot
- technologieverständnis
- technologiewettbewerb
- technologiezugänglichkeit
- technologische
- technologische autonomie
- technologische demokratisierung
- technologische durchbrüche
- technologische eigenständigkeit
- technologische entwicklung
- Technologische Entwicklungen
- technologische ethik
- technologische fortschritte
- technologische führerschaft
- technologische führungsposition
- technologische Grenzen
- technologische herausforderungen
- technologische innovation
- Technologische Innovationen
- technologische partnerschaft
- Technologische Revolution
- technologische sicherheit
- technologische singularität
- technologische transformation
- technologische überlegenheit
- technologische unabhängigkeit
- technologische verdrängung
- technologischen
- Technologischer Fortschritt
- technologischer kalter krieg
- technologischer vorsprung
- technologischer wandel
- technologischer wettlauf
- technologischer wettstreit
- technologisches wettrüsten
- Technomagier
- technosignaturen
- technosignatures
- technospiritualität
- tee-verkoster
- telecom
- telegram-partnerschaft
- telekom
- teleperformance
- telum ii prozessor
- Tencent
- Tencent Hunyuan
- tengr
- tengr.ai
- tensorflow unterstützung
- teradata
- terminal
- Terminator
- terminator-film
- terminiertes messaging
- terminplanung
- Tesla
- tesla-partnerschaft
- teslas
- test-time training
- testangebot
- Testberichter
- testdateien modifizieren
- testphase
- testumgebung
- testzeit-skalierung
- text
- text- und daten-mining
- Text-Roboter
- text-to-image
- text-to-speech-modelle
- text-zu-3d
- text-zu-bild-generierung
- text-zu-bild-konversion
- text-zu-bild-konverter
- text-zu-bild-technologie
- text-zu-gesang-konversion
- text-zu-sprache
- text-zu-sprache-modell
- text-zu-sprache-modelle
- text-zu-sprache-systeme
- text-zu-sprache-technologie
- text-zu-video
- text-zu-video-generierung
- text-zu-video-konvertierung
- textadventures
- textbefehle
- textdarstellung
- texte
- texte verbessern
- Texter
- Texterstellung
- texterzeugung
- textgenerierung
- textsätze
- textübersetzung
- Textumwandlung
- texturdetails
- texturen-generator
- textverarbeitung
- textverständnis
- the
- the midas project
- The One
- The Witcher
- thema
- thematischen
- themen,
- therapeutische allianz
- thermischer
- thermodynamisches Computing
- thinker-talker-architektur
- Thinking Machines
- Thinking Machines Lab
- thinq
- ticket-priorisierung
- TIDE-E
- tiefere verbindungen
- tiefes
- tiefgehende
- tieftemperaturforschung
- tierärztliche versorgung
- tieremotionen erkennen
- tierkommunikation
- Tiertrainer
- tierversuche
- tierversuchsfreie forschung
- tiktok
- tiktok-plattform
- tiktok-übernahme
- timesharing-systeme
- tinder
- tinders innovation
- tinywow ai
- titanen:
- tobias lütke
- token-basiertes system
- token-kontextfenster
- token-kontextmodelle
- token-nutzung
- tokenisierung
- tolle
- ton
- Ton Gewichtung
- Tonfall
- Tonfarbe
- tool
- tools:
- top
- topoleiter
- topologische materiezustände
- topologische qubits
- tote
- TOTE-Modell
- töten
- toxizitätsprofile
- TPU-Deal
- tpu-entwicklung
- tpus der siebten generation
- tracking-technologien
- traditionelle Medizin
- traditionelle methoden
- Traffic-Verluste
- tragbare ki
- tragbare technologie
- tragbares gerät
- trainer
- training
- training von ki-modellen
- trainings
- trainingsdaten
- trainingsdaten diversität
- trainingsdaten für ki
- trainingseffizienz
- trainingsmethoden
- trainingsmethodik
- trainingsprozess
- trainingsunterstützung
- Tranlation
- transaktionssicherheit
- transformation
- transformation von interaktionen
- transformative
- transformative ki
- transformator-rahmenwerk
- transformer-architektur
- transformer-architekturen
- transformer-basierte frameworks
- transformer-basierte netzwerke
- transformer-blöcke
- transformer-modelle
- transformer-technologie
- transformers
- transformers.js
- Transformers.js v3
- transforming
- transkriptionsfähigkeiten
- transkriptionsmodell
- transkriptionstool
- transkriptionstools
- transkriptomik
- Translator
- transluzenz und modernität
- transparente entscheidungsfindung
- transparente ki
- transparente ki-modelle
- transparenz
- transparenz in der forschung
- transparenz in der ki
- transparenz in der ki-nutzung
- transparenz in der ki-technologie
- transparenz in entscheidungen
- transparenz in ki
- transparenz in ki-systemen
- transparenz in ki-tests
- transparenz und fairness
- transparenz von ki-systemen
- transparenzinitiative
- transparenzinitiativen
- transparenzprobleme
- transportinnovation
- Trauer
- Trauma Geschichten
- träume
- treffen
- treiben
- treibende
- treibt
- trek
- trend
- trends
- treuepflichtverletzung
- tribeca film festival
- trick
- truck
- trump
- trump-administration
- trump-ki-agenda
- trump-tech-plan
- trumps
- trust
- tsinghua-universität
- TSMC
- tumorerkennung
- tür
- turbo
- turbo-ki-modelle
- turing award
- turing-test
- türöffner
- tutorial
- tutorial-erfahrung
- tv-episoden:
- twitch-interaktion
- Twitter Feed
- typescript
- typografiegenauigkeit
- über
- uber partnerschaft
- überarbeitung von teststandards
- Überblick:
- überbrücken
- Überbrückung
- überfordert
- Überforderung überwinden
- übergang zu ersatzmodellen
- überleben?
- Überlebensstrategien
- Überlegungen
- übermenschliche programmierfähigkeiten
- Übernahme
- übernahmeangebot
- übernatürlich?“
- Übernimmt
- überprüfung der genauigkeit
- überprüfung digitaler beweise
- überraschenden
- Übersetzer
- übersetzt
- übersetzungs-ki
- übersetzungsgenauigkeit
- Übersetzungsmodell
- übersetzungstechnologie
- überstrapazierter
- Übertriebene
- übertrifft
- Überwachung
- überwachung durch ki
- überwachung von ki
- überwachungsaufnahmen
- überwachungsmethoden
- überwachungssysteme
- überwachungstechnologien
- Überzeugung
- ui-screenshots
- ukraine
- ultimative
- ultra
- ultra tensor cores
- ultrarealistische videos
- ultraschalltechnologie
- umfassende
- umfrage
- umgang
- umgebung
- umgebungsnavigation
- umgehungsangriffe
- umgestaltung
- umhauen
- umsatzbeteiligungsmodell
- umsatzsteigerung
- umschulungsprogramme
- umstrittener
- umweltauswirkungen
- umweltfreundliche logistik
- Umweltkosten
- Umweltsanierung
- umweltschutz
- umweltüberwachung
- umweltverantwortliche technologie
- unabhängigkeit
- unabhängigkeit von google
- unautorisiertem
- unbefugte methoden
- unbefugter zugriff
- unbegrenzte
- unbegrenzte inhaltserstellung
- unbegrenzter ki-zugang
- unberechenbare
- uncanny valley
- und
- underfitting
- unendliche
- unethisch
- unethisches verhalten von ki
- unfruchtbarkeitsprobleme
- ungelöstes rätsel
- ungenauigkeit
- ungewisse
- ungewöhnliche
- ungewöhnliches
- ungewohnte
- ungleichheit
- unheilvolle
- unimate
- union
- unity!
- universal
- Universal Pictures
- universelle zugänglichkeit
- Universität Probleme
- universitäten
- universitätszusammenarbeit
- university of british columbia
- unkontrollierter
- unleashed:
- unrealistische bewegungen
- unrechtmäßige
- unschuldiger
- unsichere datenbank
- unsinnige
- Untergang
- unterhaltungserlebnisse
- unterhaltungsindustrie
- unterhaltungsriesen
- unternehmen
- Unternehmens
- Unternehmens-KI
- unternehmensanwender
- unternehmensanwendungen
- Unternehmensautomatisierung
- unternehmensbewertung
- unternehmenscybersicherheit
- unternehmensdaten
- unternehmenseinsatz
- Unternehmensentwicklung
- unternehmensführung
- Unternehmensinnovation
- unternehmensinsolvenzen
- unternehmensinvestitionen
- unternehmenskommunikation
- unternehmenskontrolle
- unternehmensnutzer
- unternehmenspakete
- unternehmensrivalität
- unternehmenssimulationen
- unternehmensstrategie
- unternehmensstruktur
- unternehmenstransformation
- unternehmensübernahme
- Unternehmensüberwachung
- unternehmensumstrukturierung
- unternehmensverantwortung
- unternehmenswachstum
- unternehmertum ohne programmierkenntnisse
- unternimmt
- unterrepräsentierte sprachen
- unterstützen
- unterstützten
- unterstützung
- unterstützung durch openai und microsoft
- unterstützung für sehbehinderte
- untersuchung
- unüberwachtes lernen
- unveils
- unvergessliche
- unvollkommenheit in der gestaltung
- unvorbereiteten
- update-fehler
- updates,
- upfront
- upgrade:
- upgrades,
- urbane zentren amazonas
- Urheberrecht
- urheberrecht im journalismus
- urheberrecht ki-generierte bilder
- urheberrechtlich geschütztes material
- urheberrechtliche fragen
- urheberrechtliche risiken
- urheberrechtsausnahmen
- urheberrechtsdebatte
- urheberrechtsfragen
- urheberrechtsgesetzgebung
- urheberrechtsklagen
- urheberrechtsreform
- urheberrechtsschutz
- Urheberrechtsverletzung
- urheberrechtsverletzungen
- Urlaub
- uruguay
- US Gericht
- US Senat
- us-aktienmarkt
- us-analyse
- us-basierte datenzentren
- us-betriebsabläufe
- US-China-Spannungen
- us-china-technologiewettbewerb
- us-chip-restriktionen
- us-dominanz
- us-erwachsenen
- us-exportkontrollen
- us-geheimdienste
- us-geschäfte
- us-gesetzgeber
- us-gesetzgebung
- us-government-beteiligung
- us-halbleitermarkt
- us-halbleiterproduktion
- us-kanada zusammenarbeit
- us-ki-politik
- us-militäroperationen
- us-regierungsbehörden
- us-techführer
- us-technologieführerschaft
- us-technologiepolitik
- us-technologievorherrschaft
- usa
- usa ki-politik
- usa und uk
- usb-stick
- user experience research
- v-jepa
- v5.1
- vae-ki-zugänglichkeit
- vakuumtechnik
- validierungsprozesse
- vall-e
- valley
- vantagecloud
- variation
- vatikan
- vatikan und künstliche intelligenz
- vektorbasierte inhaltsanalyse
- Vektordesign
- velvet sundown
- venture-finanzierung
- venture-firmen
- venture-kapital
- ventures
- Veo 2
- veo 3 ki-modell
- veraltete informationen
- veraltete sicherheitsprotokolle
- verändern
- verändernden
- verändert
- veränderung
- veränderungen
- veranstaltet
- verantwortlichkeit von ki
- verantwortlichkeiten
- verantwortung
- Verantwortung der Menschheit
- verantwortung in der ki
- verantwortungsvolle
- verantwortungsvolle innovation
- verantwortungsvolle KI
- verantwortungsvolle ki-entwicklung
- verantwortungsvolle technologienutzung
- verantwortungsvoller
- verarbeitung natürlicher sprache
- verbesse
- verbessere
- verbessern
- verbessert
- verbesserte
- verbesserte argumentation
- verbesserte bildschirmfreigabe
- verbesserte klimaüberwachung
- verbesserte maschinenbedienung
- verbesserte modellleistung
- verbesserte prompt-technologie
- verbesserte reaktionsfähigkeit
- verbesserte sicherheitsmaßnahmen
- verbesserte team chat-funktionen
- verbessertes
- verbesserung
- verbesserung der nachsorge
- verbesserungen
- verbietet
- verbindung
- verbindungen
- verblasster
- verbraucherdaten
- verbraucherentscheidungen
- verbraucherschutz
- verbraucherstrategie
- verbrauchertechnologiestandards
- verbrauchervorteile
- verbreitet
- verbündete
- verdiene
- verdienen
- verdoppelung der ki-fähigkeiten
- verdummung
- vereinen
- vereinigen
- vereinigtes königreich ki-politik
- verfahren
- verfügbar
- verge
- vergleich:
- verhaftet
- verhaftungen
- verhaltensanalysen
- Verhaltensforscher
- verhaltensforschung
- Verhaltenssteuerung
- verhindert
- verifizierbare belohnungen
- verifizierte Erwachsene
- verifizierungsstandards
- verifizierungssysteme
- verifizierungstools
- Verkäufer-Tools
- verkaufszwang
- verkauft
- verkehrssicherheit
- verkehrstechnologie
- verklagt
- verkörperte kognition
- verkünden
- Verlage
- verlagsrechte
- verlagsverluste
- verlassen
- verlässt
- verleger
- verleger einkommen
- verliert
- verlorene stadt z
- verlust menschlicher geschichtenerzähler
- vermeiden
- vernetzte fahrzeuge
- veröffentlichen
- veröffentlicht
- veröffentlichung
- verpassen
- verpflichten
- verpflichtung
- verrostetes
- verschiedene
- verschiedenen
- verschlagen!
- verschlüsselte botschaften
- verschlüsselte kanäle
- verschlüsselung
- verschollene
- verschränkung
- verschwinden
- Verschwörungstheoretiker
- verschwörungstheorien
- verspricht
- verständnis
- verständnis globaler krisen
- verstärken
- verstärkendes lernen
- verstärktes lernen
- verstärkung
- verstärkungslernen
- versteckte
- versteckter
- verstehen:
- versteht
- versuche
- verteidigungstechnologie
- verteufelung
- vertex ai
- vertragsbruch
- vertrauen
- Vertrauensbruch
- vertrauensverlust
- vertrauensvolle
- vertrauenswürdigkeit
- vertrauenswürdigkeit von ki
- vertrauliche föderierte analytik
- verwaltungsaufwand
- verwandelt
- verwandlung
- verwechslung von fakt und meinung
- verwenden:
- verwendet,
- verwickelt
- verwüstung
- verzerrungen
- vesuv
- vesuvius
- vgnn-framework
- vhs
- Vibe Coding
- Vibe Programmierung
- Vibes
- VibeVoice
- video
- Video GPT
- video-beschreibungen
- video-editing
- video-fidelity
- video-generation
- Video-KI
- video-mme-benchmark
- video-segmentierung
- video-sharing-plattform
- video-zu-code-funktionalität
- Videoanalyse
- videoaufnahmen
- videobearbeitung:
- videobeschreibung
- videodatensätze
- videoeinblicken
- videoerstellung
- videoerstellungswerkzeug
- videogenerierung
- videogenerierungstechnologie
- videografie
- videoinhalte
- videoinhalte erstellen
- videoinhaltsanalyse
- VideoJAM
- videopoet:
- videoproduktion
- videoproduktionstechnologie
- videoqualität
- videorendering-technologie
- videos
- videospiele
- videospielen
- videoverarbeitung
- videoverbesserung
- videoverständnis
- vidu:
- vielfalt
- vielfältige datensätze
- vielfaltsoptimierung
- vielseitige dateiformate
- vielseitigkeit
- vier-tage-arbeitswoche
- vigenère-chiffre
- viggle
- Vine
- vintage
- virale inhalte
- virale schwänze
- virale tanztrends
- virales potenzial
- virtual assistant
- virtual reality
- virtuelle
- virtuelle anproben
- virtuelle anprobetechnologie
- Virtuelle Assistenten
- virtuelle Assistenz
- virtuelle dating-begleiter
- virtuelle intimität
- virtuelle modellierung
- virtuelle models
- virtuelle persönlichkeiten
- virtuelle teilnahme
- virtuelle tutoren
- virtuelle umgebungen
- virtuelle umkleidekabine
- virtueller assistent
- virtuelles kamerasystem
- virtuelles team
- vision
- vision 2030
- vision-language-action-modell
- vision-language-modelle
- visionären
- visionos
- visual content verständnis
- visual effects
- visual studio code
- visualisierungen
- visuals-generierung
- visuelle
- visuelle analyse
- visuelle anfragen
- visuelle ästhetik
- visuelle automatisierung
- visuelle Bearbeitung
- visuelle computertechnologie
- visuelle effekte
- visuelle erkennung
- visuelle erkennungssysteme
- visuelle fähigkeiten
- visuelle inhalte
- visuelle innovation
- visuelle interpretation
- visuelle ki-fähigkeiten
- visuelle kohärenz
- visuelle verbesserungen
- visuellen
- visueller
- visuelles feedback
- visuelles storytelling
- vlc-media-player
- vllm-bibliothek
- VMware
- voice-ai
- voice-cloning-technologie
- vokabulargröße
- volkswagen
- volle
- vollständig
- von
- vor:
- vorantreiben
- voraus
- vorbehalte
- voreingenommene daten
- voreingenommenheit
- voreingenommenheit in ki
- vorgestellt
- vorhersage:
- Vorhersagemodelle
- vorhersagen
- vorhersagetools für gesundheitsrisiken
- vorhersagezuverlässigkeit
- vorrang
- vorschriften
- vorstandskrise
- vorstellung
- vorstellungskraft
- vorurteile
- vorurteilsreduktion
- vorwürfe
- voxtral
- vpn für zugang
- vr-technologie
- vs.
- Waatermark
- wachsende
- wachsende nutzerzahlen
- wachstum
- Wachstumsstrategien
- waffensysteme
- wahlauswirkungen auf technologie
- wahlbeeinflussung
- wahlbeeinflussungstaktiken
- wahlen
- wahlprogramme
- wahrheit
- wahrheit in der politik
- wahrheitsmanipulation
- WAIC 2025
- waldbranddetektion
- waldbranderkennung
- wallpaper
- wan 2.1
- wandel
- wappnen
- Wärmebelastung
- warnt
- Warnung
- warum
- was
- Washington
- wasserschutzklasse ipx4
- Wasserzeichen
- wayve technologie
- wearable-technologie
- wearos 6
- web
- web scraping
- web-aufgaben automatisierung
- Web-Guide
- web-interaktion
- web-navigation
- Web-Recherche
- webanwendungen generieren
- webbrowser-sicherheitsfunktionen
- webbrowsing-fähigkeiten
- webcrawler
- webdesign
- webentwicklung
- webgpu
- webseiten-änderungen
- websiteerstellung,
- websuche-integration
- websuche:
- wechsel
- wechselt
- weckt
- weg,
- wegbereiter
- wegweisende
- wehrt
- weihnachten
- Weihnachtsmarketing
- weihnachtstraditionen
- Weihnachtszeit
- Weisheit
- weiße
- Weiße Haus
- weiterentwicklung
- welt
- weltausstellung 1964
- Weltbau
- weltkrieg
- Weltmodelle
- weltraumbasierte supercomputer
- weltraumforschung
- weltweite
- weltweite Entwicklungen
- weltweiten
- wendepunkt
- werberendite
- werbesicherheit
- werbetreibende
- werbevideo
- werbung
- werkzeug?
- werkzeuge
- werkzeugintegration
- werkzeugmanipulation
- Wertsteigerung
- werwolf
- wettbewerb
- wettbewerb im technologiebereich
- wettbewerb im technologiemarkt
- wettbewerb in der ki-technologie
- wettbewerb in der suchindustrie
- wettbewerb in digitalen gesundheitsdiensten
- wettbewerber
- wettbewerbsbremsung
- wettbewerbsdynamik
- wettbewerbsfähige preise
- wettbewerbsfähigkeit
- wettbewerbsposition
- wettbewerbsverbote
- wettbewerbsvorteil
- wetten
- Wettervorhersage
- wettervorhersagen
- wettlauf
- wham-modell
- Wharton-Studie
- whatsapp-ki
- whistleblower
- wichtig
- wichtiger
- Wide Research
- widersacher
- wie
- wiederbelebt
- wiederholung
- Wiederverwendbarkeit
- Wikinger
- wikipedia
- wildes
- willow-chip
- wimbledon-tennisturnier
- windows
- Windows 2030
- windows-nutzer
- windsurf
- windsurf kauf
- wird
- wirkstoffkandidaten
- wirkt
- wirkung
- wirkungsvolle
- Wirtschaft
- wirtschaft:
- wirtschaftliche
- wirtschaftliche auswirkungen der ki
- wirtschaftliche effizienz
- wirtschaftliche expansion
- wirtschaftliche gerechtigkeit
- wirtschaftliche umwälzungen
- wirtschaftliche ungleichheit
- wirtschaftlicher
- wirtschaftlichkeit
- wirtschaftswachstum
- wirtschaftswachstum deutschland
- wissen
- wissensbasierten
- wissensbeschaffung
- wissenschaft
- wissenschaftler
- wissenschaftler-exodus
- wissenschaftliche autonomie
- wissenschaftliche entdeckung
- wissenschaftliche entdeckungen
- wissenschaftliche forschung
- wissenschaftliche innovation
- wissenschaftliche innovationen
- wissenschaftliche integrität
- wissenschaftliche meilensteine
- wissenschaftliche pioniere
- wissenschaftliche publikation
- wissenschaftliche standards
- wissenschaftliche strenge
- wissensdateien
- wissensrepräsentation
- Wissenssuche
- wissenstransfer
- with
- wiz research
- woche
- wochenmitte
- wöchentliche nutzer
- wohnkomfort
- wolf
- workarounds
- Workflow
- workflow-analyse
- workflow-optimierung
- workflows
- workouts
- workspace
- World Labs
- worldcoin?
- WormGPT
- wörter
- wörtern
- worthäufigkeit
- worüber
- writer
- writers guild of america east
- writers guild of great britain
- writesonic
- wunderbare
- wunderwerke
- wurde.
- wüste
- wwdc
- wwdc 2025
- x plattform
- x premium+
- x social media
- x’s
- xAI
- xai grok 3
- xai holdings corp
- xai’s
- Xcode
- xcode 8.0
- Xerox PARC
- xGen-MM-Vid
- xgen-mm-vid-modell
- xi jinping
- Yann Lecun
- yi-34b
- yolov8
- Yoshua Bengio
- youtube
- YouTube Shorts
- youtube-kanaelen
- youtube-ki-updates
- youtube-monetarisierung
- youtube-videos
- YouWare
- yvonne gonzalez rogers
- zahlungsmethodenvielfalt
- zahnröntgenbildern
- Zapier
- Zauberer
- zauberhaften
- zeichnung
- zeit
- zeitalter
- zeitmanagement
- zeitschrift
- Zelda Williams
- Zellalterung
- zensur
- zensurnormen
- zero-shot-fähigkeit
- zero-shot-prompting
- zerosearch
- zerstören
- zieht
- zielgruppen-targeting
- zimmwriter
- zitieren:
- zollauswirkungen
- zombie
- zoom drive
- zoom updates
- zoom’s
- zuckerberg
- zuckerbergs
- zug
- zugang
- zugang zu ki-technologie
- zugang zur ki
- zugängliche technologie
- zugänglichkeit
- zugänglichkeit in der therapie
- zugänglichkeit von ki
- zugänglichkeitstechnologie
- zugangskontrolle
- zugangskontrollen
- zugangsmodell
- züge
- zugriff auf aktuelle informationen
- zugriffskontrollen
- Zuhause
- zukünftige Technologien
- zukunft
- Zukunft der Arbeit
- Zukunft der KI
- zukunft der programmierung
- Zukunft der Technologie
- zukunft der websuche
- zukünftige
- zukünftige Entwicklungen
- zukünftiger journalismus
- zukünftiges
- Zukunftsfähige Kinder
- Zukunftsperspektiven
- zukunftspläne
- zukunftsszenarien
- Zukunftstechnologie
- Zukunftstechnologien
- zunahme
- zur
- zurückhaltung
- zusammen,
- zusammenarbeit
- zusammenhang
- zusammentun
- zuverlässigkeit
- zuverlässigkeit der ki
- zuverlässigkeit von ki
- zweischneidiges
- 💻✍️